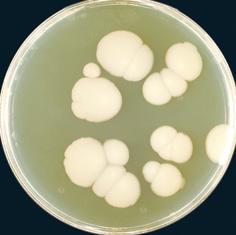

Ідентифікатор
2024, вересень
ЧЕРНИХ Валентин Петрович, академік НАН України д.
фарм. н., д. хім. н., професор, заслужений діяч науки і техніки України, почесний ректор НФаУ
ШТРИГОЛЬ Сергій Юрійович — д. мед. н., професор, зав. кафедри фармакології та фармакотерапії НФаУ ВОЛЯНСЬКИЙ Андрій Юрійович, лікар-імунолог, доктор
медичних наук, завідувач лабораторії імунореабілітологі Інституту імунології та мікробіологі ім. Мечнікова
ГЛАДИШЕВ Віталій Валентинович, д. фарм. н., професор, зав. кафедрою технології ліків
терапії №1 Запорізького державного медикофармацевтичного університету ТРОХІМЧУК Віктор Васильович, д. фарм. н., професор, завідувач кафедри організації та економіки фармації НМАПО ім. П.Л. Шупика, заслужений працівник освіти України
ПРИСЯЖНЮК Петро Васильович, к. хім. н., доцент кафедри медичної та фармацевтичної хімії Буковинського державного медичного університету ДАВТЯН Олена Левонівна, д. фарм.н., професор,
в.о. ректора Національного фармацевтичного
університет
Вельмишановна Алло Анатоліївно, які найбільш важливі події відбулися в Національному фармацевтичному університеті впродовж минулого навчального року? Якими
досягненнями колективу Ви
особисто пишаєтеся?
Моя найбільша гордість — це колектив Національного фармацевтичного університету. Умови проживання у місті непрості, слово «безпека» втратило свою гостроту, присутнє
відчуття перманентного стресу, працювати доводиться переважно в онлайні…
Пишаюся тим, що освітні програми «Фармація»
та «Технології фармацевтичних препаратів» спеціальності 226 Фармація, промислова фармація отримали зразкову акредитацію. Вперше. Єдині в Україні.
Чи сприятливі ці фактори? Але ядро колективу
збережено практично повністю, викладачі віддано працюють, готують кадри і дуже багато волонтерять.
Певна кількість наших співробітників стала до лав
ЗСУ. Ось це саме ті моменти, якими пишаюся!
Якщо говорити про власне освітній процес, то
пишаюся тим, що освітні програми «Фармація» та «Технології фармацевтичних
Пишаюся також міжнародними активностями, які не лише збережені на довоєнному рівні, але й зросли. І здобувачі освіти, і викладачі здійснюють чимало академічних мобільностей, зокрема, й за програмою Еразмус+.
Як в умовах воєнного часу вдається не тільки долати труднощі,
але й зберігати лідерство у
фармацевтичній галузі і розвивати
нові напрями діяльності?
Все достатньо просто пояснюється: три чверті працівників нашого університету
дисертації. Вони зростали разом із університетом, переживали негаразди, раділи здобуткам, не розділяючи власне життя та життя НФаУ. Напевно, тому середній стаж роботи працівника у
— майже 30 років. Долати труднощі легше
всі
ні на результат. Цього року ми, як й інші українські заклади вищої освіти, особливо гостро відчуваємо дефіцит вступників. Увесь колектив, крім забезпечення освітнього процесу, наукової роботи, потужно став до здійснення профорієнтації. Не треба забувати, що
відсутність у нас вступника сьогодні — кадрова проблема сфери охорони здоров’я завтра, тому це соціаль-
на відповідальність НФаУ. Ми це чітко усвідомлюємо
й працюємо всім колективом. Стартувала робота зі створення у межах КЗ «Хар-
ківська обласна Мала академія наук Харківської обласної ради» гуртка «Фармація», бо це є актуальним напрямом, проведено МетроШколу «Чарівний світ фармації», опрацьовано цілу низку онлайн науково-популярних заходів із природничих наук… Власне, профорієнтація логічно перемістилася у електронний простір. І начебто звучить це легко, але це величезна робота кожного нашого працівника! Ми завжди вміли будувати стратегію розвитку, робимо це й зараз. У межах свого цінного ресурсу — спадковості та
фармацевтичної
товки через Фаховий коледж, університет та Інститут підвищення кваліфікації спеціалістів фармації — удосконалюємо якість, розширюємо горизонти підготовки. У 2024 р. проліцензували інтернатуру за спеціальністю «Лабораторна діагностика, вірусологія, мікробіологія». Готуємо магістрів освітньої програми «Лабораторна діагностика» спеціальності 224 Технології медичної діагностики та
лікування, повинні дати їм можливість пройти інтернатуру та забезпечити навчання протягом професійного життя. Також на вимогу часу здійснено роботи з відкриття
низки вторинних спеціалізацій. У партнерстві з Аптечною мережею «Аптека 911» відкрили нестандартний фармацевтичний простір — PharmHub на Сумській.
Яка мета? Масштабування взаємодії у питаннях зменшення кадрового голоду, популяризації професії фармацевта. PharmHub — це креативний простір для реалізації неформальної та інформальної освіти, проведення майстер-класів, створення бізнес-проєктів, організації спільних івентів. Чимало проєктів реалізовано, чимало ще чекає на втілення наступного навчального року. Які заходи проводить НФаУ для забезпечення високого рівня якості надання освітніх
PharmHub
розроблено
нормативну базу, створено центр дистанційних технологій навчання, підготовлено навчально-методичні кейси, відкрито відеостудії. Наші викладачі пройшли відповідну підготовку й отримали сертифікати, а з 2018 року, вже у нашому внутрішньому освітньому середовищі, в ІПКСФ НФаУ, започатковано підвищення кваліфікації за програмою «Теорія та практика дистанційного навчання». Завдяки потужному досвіду у 2020 році під час пандемії COVID-19 наш колектив практично не зупиняв освітній процес, досить швидко перелаштувався на роботу у форматі онлайн. Понад те, дистанційно була проведена державна атестація, прозоро, у суворих рамках, з надійною автентифікацією випускників. Сьогодні 100 % НПП — сертифіковані т’ютори, 100 % дисциплін усіх спеціальностей, курсів, форм навчання забезпечені
відними навчальними матеріалами, відшліфовано
проведення контрольних заходів. Для зручності здобувачів освіти працюють освітній
портал НФаУ, сайт дистанційного навчання НФаУ, сайт
дистанційного навчання ІПКСФ НФаУ, сайт дистанційного навчання Фахового коледжу НФаУ, сайт для підготовки до складання ліцензійних інтегрованих іспитів КРОК, сайт Наукової бібліотеки НФаУ, онлайн-платформа сервіс «Кар’єра та працевлаштування». Ці ресурси охоплюють повний цикл підготовки фахівця аж до працевлаштування та підвищення кваліфікації.
Електронна система навчання НФаУ розміщена на платформі Moodle, для зручності доступу здобувачі освіти користуються системою «Університет в смартфоні».
Викладачами Національного фармацевтичного університету розроблено унікальний проєкт МетроШкола «Чарівний світ фармації»
для школярів Харкова. Яка мета та результати цієї освітньої ініціативи?
МетроШкола — це безпреце-
дентний проєкт під патронатом
Харківського міського голови Ігора Терехова, що був задуманий та реалізований з метою забезпечення продовження навчання юних хар-
ків’ян за партами, наживо, в нинішніх скрутних умовах. Проєкт дозволив пев-
ній частині харківських школярів вийти в
офлайн-формат навчання, спілкуватися зі своїми однолітками, певною мірою соціалізуватися, що є надзвичайно важливо з огляду на ті освітні умови, в яких знаходиться шкільна молодь,
COVID показала важливість фармацевтів у забезпеченні
університету, що ми були вимушені ледь не конкурс проводити
у форматі
учнів
ралася на актуальність питань для сучасної молоді. Це, зокрема, здоровий спосіб життя, здорове харчування, надання першої медичної допомоги, виявлення фальсифікованих ліків та продуктів у домашніх умовах тощо. Цікаві досліди власноруч, практичні навички отримали діти на заняттях «Готуємо крем власними руками», «Догляд за проблемною шкірою», «Проводимо хімічне розслідування і визначаємо фальсифікацію ліків та продуктів харчування», «Кольорові перевтілення органічних сполук», «Енергетичні напої: наскільки вистачить енергії?», «Вітаміни — молекули життя», «Хімія буває фармацевтичною», «Чи так безпечні вейпи?», «Сучасні методи контрацепції», «Шоколадо- та кавоманія». І це далеко не повний перелік
проведених занять.
Опитування, які були проведені серед школярів, продемонстрували, що 95 % респондентів оцінили
заняття у МетроШколі «Чарівний світ фармації» на
високому рівні. На мою думку, це дуже непоганий
показник і, безперечно, якусь кількість цих дітей ми побачимо у подальшому в якості наших студентів.
Національний фармацевтичний університет відомий своїм потужним студентським самоврядуванням. Які основні напрямки його діяльності?
Так, Національний фармацевтичний університет славиться своїм потужним студентським самоврядуванням. Воно є важливим елементом університетського життя, адже саме воно сприяє розвитку особистості здобувача освіти та формує активну громадську позицію. Ми всіляко підтримуємо це, університет декларує і практично втілює принцип студентоцентричності.
Ця інституція студентської активності — справжній епіцентр молодіжної ініціативи, де
концентруються студентські лідери університету.
Саме вони ініціюють безліч проєктів та івентів, які
позитивно впливають як на навчальну, так і на поза-
навчальну атмосферу. Фармацевтична молодь сама визначила напрями своєї діяльності. Наприклад, проєктний сектор —
лення ідеї в життя, тут «народжуються» ініціативи
спільною метою допомагати іншим, влаштовує благодійні акції, підтримує соціально вразливі верстви населення, бере участь у численних волонтерських проєктах. Цей сектор організовує університетську громаду на участь у донорстві крові й плазми. PR-сектор — «голос» молодого університету, що ширить інформацію про студентське життя за межі Alma mater. Молодь генерує контент, який популяризує фармацію, просуває університет у соціальних мережах, а також організовує рекламні кампанії й інформаційні заходи. Сектор наукової та інтелектуальної діяльності — молодіжний «мозковий центр», де здобувачі освіти мають можливість зануритися у світ науки й інтелектуальних відкриттів. Цей сектор підтримує науковців-початківців, надаючи їм можливість розвиватися, ділитися
самоврядування у такому вигляді створює у НФаУ унікальну атмосферу студентського життя.
Які основні здобутки волонтерського руху Національного фармацевтичного університету?
Ми багато років підтримуємо КЗ «Харківська спеціальна школа № 8», КЗОЗ «Обласний будинок дитини № 3», гематологічне відділення КНП «Міська дитяча клінічна лікарня № 16», також активно співпрацюємо з Biopharma Рlasma. Наші викладачі, співробітники та здобувачі освіти є постійними донорами.
На початку повномасштабного вторгнення наші
викладачі та студенти волонтерили на аптечних складах. Пишаємося нашими науковцями, які створили унікальні ліки для наших захисників: кровоспинний засіб місцевої дії з антисептичним ефектом «PLANTOR», призначений для зупинки зовнішньої кровотечі різної інтенсивності; засіб для профілактики відморожень «ГЛЮЦИНКОВІТ»; бинт гофрований «Гемостатик».
Волонтерський рух у нашому університеті завжди був потужним, таким залишається і сьогодні.
Волонтерський сектор студентського самоврядування спільно з відділом організації виховного процесу та соціальних питань займається розробкою, пошуком, залученням університетської спільноти до волонтерських ініціатив. Їхній спектр надзвичайно широкий. У вересні 2023 р. студентська спільнота провела акцію «Подякуй військовим», а в листопаді 2023 р. університет долучився до Всеукраїнської акції «Смілива гривня». Наші співробітники й студенти постійно
виготовляють окопні свічки та передають їх захисни-
кам України, волонтерять у проєктах з виготовлення
маскувальних сіток. Цьогоріч була реалізована акція
«Великодній смаколик», у рамках якої було зібрано донати на потреби ЗСУ.
Наша молодь співпрацює з благодійним фондом
«Центр здоров’я та розвитку дитини», підтримує підлітків з інклюзією. У рамках спільної діяльності долучилися також до допомоги Фельдман Екопарку. Крім того, фармацевтична молодь є учасником
міської школи волонтерства
була охоче підтримана роботодавцями
ми фармацевтичними підприємствами й аптечними мережами України. Від моменту генерації ідеї до її
лення кожен крок синхронізувався з ними. Нам разом вдалося оперативно опрацювати механізми
прозорі методи визначення найкращих здобувачів освіти
на стипендіальну програму достатньо суворий. Претенденти,
ніж 100 здобувачам освіти. Загалом роботодавці виплатили їм понад 1 млн грн. Академічна спільнота та студентство НФаУ щиро вдячні нашим партнерам-учасникам «Стипендіального проєкту». Наразі можемо впевнено констатувати, що результати співпраці з практичним сектором свідчать про своєчасність і результативність соціальної ідеї.
Які можливості надає НФаУ для талановитої молоді? Як реалізується академічна мобільність здобувачів вищої освіти під час війни?
Здобувачі освіти в Національному фармацевтичному університеті мають безліч можливостей для реа-
лізації своїх здібностей в усіх сферах, адже університет — це не лише про навчання та науку. Це й спорт, і
медіа, і волонтерство, і студентське самоврядування...
Щороку ми започатковуємо нові ініціативи. Також ідеї
пропонує наша молодь, і ми втілюємо їх разом. Надзвичайно важливою під час війни стала академічна мобільність. НФаУ має вже понад 10 років
досвіду участі у програмі Еразмус+. На початку повномасштабного вторгнення наші студенти перебували у Варшавському та Познанському медичних університетах, і ми вдячні колегам за їхню підтримку.
Додаткові можливості нам надали наші надійні партнери — Литовський університет наук здоров’я,
Університет Тарту, Університет Вітовта Великого.
Впродовж останніх двох років розпочалася співпраця
із вищими закладами освіти Чехії, Фінляндії, Італії, а також Франції, звідки зовсім нещодавно повернулася
делегація НФаУ.
Тож наші здобувачі освіти мають змогу навчатись
офлайн, проходити стажування та виконувати наукові дослідження на базі потужних закордонних вишів. З урахуванням поточної ситуації в Харкові це чудова можливість. Академічна мобільність зростає, паралельно напрацьовуються інші освітні та наукові
Ополе та долучилися до міжнародних стажувань. Спільні наукові проєкти реалізуються з Університетом Палермо, Литовським університетом наук здоров’я, UCL School of Pharmacy (Великобританія). У 2023 році представники НФаУ у складі групи науковців з Великої Британії, Польщі, України стали переможцями конкурсу і отримали грант від Global Engagement Funds (GEF) 2023/24 з проєктом «Nanofibers for Ukraine: Local upskilling, network building, and potentially life-saving medicines».
У рамках гранту — проведення дослідження на базі включених університетів зі створення нової розчинної
розширенням кола партнерів, адже це є запорукою та можливістю розвитку попри складні умови сьогодення.
Як відбувається освітнє партнерство НФаУ із закладами загальної середньої освіти та Малою академією наук?
Ми не говоритимемо про традиційні лекції, майстер-класи та лекції онлайн. Це було й триває, видозмінюючись та набуваючи нові форми.
Хочу розповісти про кілька унікальних проєктів, оскільки у партнерстві із закладами середньої освіти надважливо знаходити новий формат.
У квесті взяли участь 111 учнів 29 харківських ліцеїв. Діти у складі 9 команд захоплено й активно розкривали таємниці фармації, фармакології, хімії, фармакогнозії на локаціях, підготованих викладачами НФаУ: PRO_ДЖУНГЛІ, PRO_КЛІТИНИ, PRO_ЗБЕРЕЖЕННЯ ЖИТТЯ, PRO_КРАСУ, PRO_ДІЮ ЛІКІВ.
Змагання, емоції, враження, креатив, нові знання
й спілкування. Цього досить, щоб узагальнити івент.
У лютому-березні викладачі НФаУ готували шко-
лярів 8-11 класів Харкова й області до Всеукраїнської
олімпіади з біології. Із дітьми пройдено теоретичний курс та цикл відпрацювань практичних навичок.
Достатньо складно було організувати цей процес, бо має забезпечуватися безсумнівна
викладачі виконали це завдання. У підсумку Харківщина отримала трьох (!) переможців.
Серед низки проведених онлайн науково-пізнавальних заходів можу виділити онлайн курс «BIOTECH4YOU». До нього долучилися майже 100 школярів та колежан, яким цікавий цей напрям.
Ще один прорив 2023 року — посилення взаємодії з МАН. З Харківською обласною малою
академією наук Національний фармацевтич-
ний університет працює давно й результативно.
Тільки у 2023 році викладачі НФаУ здійснювали консультування 16 школярів, які викону-
вали роботи МАН за широкою тематикою —
від організаційно-економічних аспектів і діджиталізації у сфері охорони здоров’я, біотехнологічних досліджень
фармацевтам — «Фармація», «Клінічна фармація», «Організація і управління фармацією», «Контрольно-аналітична фармація», «Фармацевтична косметологія», «Фармаконагляд», «Клінічні дослідження», «Оцінка медичних технологій»; асистентам фармацевта — «Фармація»; лікарям — «Фармаконагляд», «Клінічні дослідження», «Оцінка медичних технологій».
Серед них три спеціалізації («Фармаконагляд», «Клінічні дослідження», «Оцінка медичних технологій») — це нові, на вимогу часу відкриті у 2024 році. Звісно, для фармацевтів та лікарів передбачено різний термін підготовки. Так, фармацевти будуть навчатися
3 місяці, лікарі — 6. Варто підкреслити, що до викладання за цими спеціалізаціями долучаються представники практичної фармації, регуляторних органів, зокрема, Держлікслужби та ДЕЦ.
Також ІПКСФ НФаУ у освітньому кейсі має цикли тематичного удосконалення, семінари для фахівців сфери охорони здоров’я, цикли підвищення кваліфікації для викладачів закладів освіти.
У структурі Національного фармацевтичного університету функціонує Фаховий коледж та Інститут підвищення кваліфікації спеціалістів фармації. Які можливості
це створює для подолання кадрового
дефіциту на фармацевтичному ринку?
Насамперед, це створює умови для забезпечення
спадковості фахової підготовки, а для працівника
сфери охорони здоров’я це не тільки необхідність, яка
підтримує конкурентоспроможність на ринку праці. Це, у першу чергу, вимоги законодавчі, зокрема, щодо
системного підвищення кваліфікації.
На мою думку, кожен заклад вищої освіти має бути
носієм та транслятором нових знань, досвіду, тенденцій. Молодь, яка одного разу обрала фармацію своєю
професією, має блискучі можливості — забезпечені
кадрово, методично, організаційно — у стінах одного освітнього комплексу пройти шлях від фахового молодшого бакалавра до магістра фармації, у подальшому підтримувати актуальність знань
цевтичного ринку.
консультаційно супроводжуючи потенційних вступників від реєстрації на НМТ до подання заяв на вступ. Крім того, маємо ще один напрямок — партнерство з Центром зайнятості, який надає ваучери на навчання Це практичні кроки, які спрямовані
Які заходи вживає НФаУ для формування системи безперервного професійного розвитку фармацевтичних працівників?
Наш університет завжди прагне до беззаперечної якості та досконалості у своїй діяльності й тримає руку
спрямування, наукові установи, фахові асоціації, комерційні організації. На мою думку, надзвичайно важливо, щоб конкуренція у наданні освітніх послуг БПР була прозорою, здоровою, а власне освітні послуги — якісними. Нами проаналізовано реєстр заходів БПР за 2023 та 2024 рр. Ми встановили, що заходи, які пропонуються провайдерами, не завжди специфічно спрямовані, оскільки проводяться для заширокого кола фахівців. Погодьтеся, фах лікаря, стоматолога, фармацевта, попри приналежність до спільної галузі 22 Охорона здоров’я,
принципово різні. Проведення спільних заходів БПР
не лише не враховує специфіку професійної діяльності, а й може виглядати як профанація. Саме тому ми
вважаємо, що ліцензовані суб’єкти освітньої діяльності можуть входити до системи БПР без реєстрації та з принципово іншим рівнем контролю, а ось питання щодо важелів моніторингу якості БПР залишається відкритим. Нашим науково-педагогічним корпусом опрацьовані заходи неформальної та інформальної освіти. Понад те, тематичне навчання як один із заходів неформальної освіти системи безперервного професійного розвитку, зокрема, семінари, ми почали проводити з 2020 року. Наразі цю роботу продовжуємо.
Однак маємо проблему: досі не затверджено наказ
МОЗ України, який встановлює норми нарахування
балів за заходи БПР для фармацевтичних працівників.
Нами постійно оновлюються освітні програми на
до- й післядипломному рівні, впроваджуються нові
цикли спеціалізації та тематичного удосконалення. У
заходах БПР для фармацевтичних працівників нами
пропонуються нові цікаві теми. Формуванню про-
позицій передує обов’язковий моніторинг питань, що включені до заходів, стосовно їх актуальності та затребуваності. Крім того, НФаУ працює над подоланням бар’єрів
фармація стали чотири наші
«Фармація», «Технології фармацевтичних препаратів», «Клінічна фармація», «Технології парфумерно-косметичних засобів». До речі, напередодні 25-річчя Дня фармацевтичного працівника України, Постановою Кабінету Міністрів України від 30.08.2024 № 1021 «Про внесення змін до переліку галузей знань і спеціальностей, за якими здійснюється підготовка
викладацький склад. За підручниками професорів та доцентів НФаУ навчається вся країна. 98 % наших
викладачів — доктори і кандидати наук, експерти у сво-
сучасних лабораторій для навчання, сучасного оснащення, унікальної бази для наукових досліджень. Ми активно підтримуємо амбіції студентської молоді та допомагаємо щодо участі у конкурсах наукових проєктів або академічної мобільності. Сертифіковані лабораторії для виконання досліджень із синтезу нових речовин, дослідження лікарських рослин, одержання різних лікарських форм, дослідження фармакологічної активності, ліцензовані бази даних для маркетингових досліджень — це далеко на повний перелік можливостей, які надаємо нашій молоді, причому як в оффлайн, так і в онлайн-форматах.
Пильна увага приділяється практичній підготовці.
Бази практик — це потужні відомі вітчизняні виробничі, аптечні бренди.
Вельмишановна Алло Анатоліївно, що Ви побажаєте цьогорічним
випускникам Національного фармацевтичного університету?
За таких умов, результатом навчання у НФаУ стає грунтовна хімічна підготовка, глибока зануреність у чарівний світ лікарських рослин, опанування секретів мистецтва створення ліків і
успішного фармацевтичного бізнесу.
Яким Ви бачите майбутнє Національного фармацевтичного університету?
Ми прагнемо до того, щоб Національний фармацевтичний університет залишався, як і сьогодні, провідним вітчизняним університетом фармацевтичного профілю.
Звісно, ми хочемо, щоб загули голосами студентів наші аудиторії. Університет сумує за живим спілкуванням з молоддю. Таким і бачимо наш університет: молодим, енергійним, успішним, науковим. Фармацевтичним.
Випускникам бажаємо бути
Форум відбувся у одному з найкращих залів Вінниччини — готелі «Франція». Організатори заходу на
чолі з Головою правління ГО «Вінницька обласна асоціація фармацевтів «Кум Део» Ларисою ПРОСЯНИК гостинно, по-святковому зустрічали гостей і учасників.
Серед них — представники органів державної влади й місцевого самоврядування, керівники професійних асоціацій і громадських організацій, топ-менеджери аптечних мереж і фармацевтичних компаній, викладачі і здобувачі закладів фармацевтичної й медичної освіти, фармацевти, асистенти фармацевтів, завідувачі
областей, представники спеціалізованих ЗМІ. У режимі офлайн у форумі взяли участь більше 250 фахівців, значно більша кількість долучилися до прямої трансляції в YouTube. Програма заходу передбачала привітання з нагоди Дня фармацевтичного працівника України та нагородження кращих фахівців почесними грамотами, науково-практичну частину, а також відкриття конкурсу «Фармацевт — звучить гордо!» і нагородження переможців у п’яти номінаціях. Особливо емоційною й урочистою була церемонія відкриття і привітання
ники Форуму хвилиною мовчання вшанували пам’ять
героїв, що віддали своє життя за Україну, а також тих корифеїв фармацевтичної галузі, хто нещодавно пішов з життя — доктора фармацевтичних наук, професора, Директора інституту підвищення кваліфікації спеціалістів фармації НФаУ Олександра Фоміча Пімінова та
доктора медичних наук, професора ВНМУ імені М.І.
Пирогова. Ольги Олександрівни Яковлевої.
З великою увагою учасники Форуму прослухали привітання народного депутата України Сергія
Кузьміних, начальника управління медичних кадрів, освіти і науки Міністерства охорони здоров’я України, доктора фармацевтичних наук, професора Сергія Убогова, директора громадської спілки «Європейська фармацевтична асоціація» Івана Задворних, директора громадської спілки «Аптечна професійна асоціація України», кандидата біологічних наук, провізора вищої категорії, магістра державного управління, заслуженого працівника фармації України Ірини Суворової Під час науково-практичної частини Форуму
були представлені важливі досягнення європейської та вітчизняної фармації, обговорювалися актуальні науково-практичні питання фармацевтичної галузі в Україні та за кордоном, висвітлено передовий досвід фармацевтичних компаній.
Особливо яскравими, змістовними й високопрофесійними були виступи закордонних колег, зокрема, Алли Токарчук — міжнародного експерта з питань фармації (м. Базель, Швейцарія); Ганни Бур’ян — кандидата фармацевтичних наук (Австрія, Хорватія); доктора Менона — голови правління Індійської
асоціації фармацевтичних виробників (ІРМА), Іона
Згирку — голови Національної Ради асоціації фармацевтів Республіка Молдова).
і близьких».
Доповідь на тему «Остеоартроз. Актуальність захворювання та його лікування» представлена Андрієм Макогончуком, кандидатом медичних наук, доцентом кафедри травматології та ортопедії Вінницького національного медичного університету ім. М.І. Пирогова. Лариса Вознюк, кандидат медичних наук, доцент кафедри клінічної фармації та клінічної фармакології Вінницького національного медичного університету ім. М.І. Пирогова виступила з доповіддю «Стрес та ментальне здоров’я».
Каріна Марченко, кандидат медичних наук, лікар-дерматокосметолог представила доповідь «Краса під час війни. Як догляд за собою допомагає зберегти фізичну та емоційну рівновагу під час травмуючих подій».
Найбільш очікуваним і хвилюючим дійством стало оголошення результатів і визначення переможців конкурсу «Фармацевт — звучить гордо!»
Переможцями конкурсу в номінації «Кращий завідувач аптеки» стали: Удовенко Олександра Валеріївна (ПП «Конекс»)
м.
Перемогу у номінації
«Кращий фармацевт» здобули:
Семко Людмила Михайлівна (КП «Фармація»,
Київ) — I місце.
Глєбова Ірина Іванівна (ТОВ «Фармастор») — ІІ
місце.
Мартощук Леся Василівна (ТОВ «Подорожник») — ІІ
місце.
Присяжнюк Анастасія Олегівна (ПП «Конекс») — ІІІ
місце.
Кордонська Ірина Василівна («Аптека оптових цін») — ІІІ місце.
У номінації «Кращий асистент фармацевта»
перемогли:
Дворжецька Віталія Віталіївна (ТОВ «Подорожник») — І місце.
Стрельбіцька Наталія Володимирівна (ПП «Богдан») — ІІ місце.
Демішкан Ольга Вікторівна (ПП «Конекс») — ІІ місце.
Костик Ольга Василівна (ПП «Конекс») — ІІІ місце.
Туз Валентина Володимирівна («Фармація», м. Київ) — ІІІ місце.
Відзнаку «Кращий клінічний фармацевт»
отримали:
Михайленко
спілкою «Європейська фармацевтична асоціація». Із заключним словом і підбиттям підсумків Форуму, теплими побажаннями, а також зі словами подяки за участь у Форумі та Конкурсі виступила ініціатор, Голова оргкомітету,
— ІІ місце. Карпенко Світлана Василівна (КНП «Ямпільська територіальна лікарня») — ІІІ місце.
Чичикіна Ірина Геннадіївна (КНП «Лікарня Придніпровська», м. Кременчук) — ІІІ місце.
Перемогу у номінації «Кращий студент» здобули: Ковальчук Марія (Житомирський базовий фармацевтичний фаховий коледж Житомирської обласної ради) — І місце.
Дубінець Катерина (Рівненська медична академія Рівненської обласної ради) — ІІ місце. Бідзіля Назарій Вінницький
Д. К. Заболотного) — ІІІ місце. Блажеєв Владислав
нові ділові знайомства і професійні комунікації,
«25 років — це чверть століття, а значить
у нас є певний досвід, висновки, робота
над помилками і бачення майбутнього. Це також і відповідальність перед клієнтами і працівниками. Ми раді, що залишаємося стійкими до викликів і люди продовжують
нас обирати. Завжди працювали і працюємо, щоб якнайкраще забезпечити їхні потреби», — розповів СЕО мережі аптек "ПОДОРОЖНИК" Тарас Коляда.
Компанія постійно залучає нових клієнтів і працює над тим, щоб вони залишалися
«Ми ніколи не зупиняємося і дбаємо, щоб кожен у нашій команді розвивався і розвивав компанію, відчуваючи причетність до її результатів. У
що головне в компанії
Мобільна аптека "ПОДОРОЖНИК" стала першою аптекою такого формату в Рівненській області. Свою роботу вона розпочала у червні 2024 року й обслуговує 45 віддалених населених пунктів регіону. Головна мета ініціативи — покращити доступ до необхідних медикаментів людей у селі та забезпечити високоякісне обслуговування.
«У нас було і є багато звернень щодо відкриття таких аптек і це ознака того,
вав Тарас Коляда. «Мені дуже приємно, що нас обирають для того, щоб отримати препарати за урядовою програмою «Доступні ліки» та іншими. Зауважу, що в середньому на місяць ми відпускаємо близько 180 000 рецептів за Доступними ліками й це найкращий показник серед аптечних мереж на ринку. Також за цією програмою ліки надає і наша мобільна аптека "ПОДОРОЖНИК", яку ми відкрили на Рівненщині. Ми зробили все, щоб це було можливо й оснастили цю аптеку інноваційними рішеннями, як-от системою зв’язку Starlink», — сказав Тарас Коляда.

Мережа аптек "ПОДОРОЖНИК" за 25 років роботи зарекомендувала себе як соціально відповідальна компанія, що надає благодійну допомогу за різними напрямками. Допомагають військовим і волонтерам, виконуючи конкретні запити. Підтримують також українську культуру, науку та спорт, дбають про дітей і їхнє дозвілля. «Нещодавно ми отримали нагороду LOVEMARK-КОМПАНІЯ від Всеукраїнської премії за кращий клієнтський досвід UKRAІNIAN CX EXELLENCE. Це приємна відзнака, яка для нас багато чого означає. Та ми не будемо на цьому зупинятися чи збавляти темп. Працюємо далі, щоб українці нам довіряли, любили й обирали. Продовжуємо і наші благодійні та соціальні проєкти, бо це важливо»,
c.21
Серрата® – оптимальне рішення для управління запаленням
c.26
c.27
c.34
Професійні та чуйні. «Аптека доброго дня» вітає фармацевтів з професйним святом
Отикаїн-Здоров’я — надійний
захист проти болю та запалення
при отиті
Цинабсин: дихай носом вільно — як подолати риносинусит природним шляхом
c.40
c.42
Понад 110 мільйонів гривень на благодійність спрямувала мережа аптек «АНЦ» підтримуючи країну
З фармацією в серці: до 10-річного ювілею Громадської організації «Вінницька обласна асоціація фармацевтів «Кум Део»
Серрата®–
ДЛЯ УПРАВЛІННЯ ЗАПАЛЕННЯМ
Одну із ключових ролей в розвитку гострого та хронічного болю відіграє запальний процес. Запалення — циклічний процес, що виникає у відповідь на пошкодження; він включає системну, а також локальну гуморальну і клітинну реакції, спрямовані на усунення прозапального агенту, видалення зруйнованих внаслідок пошкодження клітин та елементів міжклітинного матриксу.
Запальний процес — це універсальна реакція
організму на дію пошкоджуючих чинників екзогенного та ендогенного походження.
Патогенетичну основу запалення становлять три компоненти (стадії) — альтерація, ексудація та проліферація, які тісно взаємопов’язані між собою, взаємно доповнюють і переходять одна в одну, не маючи чітких меж. Запалення завжди починається з пошкодження тканини, комплексу обмінних, фізико-хімічних та структурно-функціональних змін, тобто з альтерації тканини, яка відіграє роль пускового фактору запального процесу [1].
Різноманітні за походженням пошкоджуюючі фактори викликають багато в чому стереотипний у своїх проявах процес, що включає місцеві зміни у вигляді альтерації тканин і
гіперемії), активація процесів вільнорадикального окиснення, накопичення в тканинах продуктів розпаду і порушеного обміну речовин. Затримці рідини в тканинах також сприяє порушення відтоку лімфи. Накопичення у вогнищі ураження продуктів порушеного обміну призводить до ацидозу, підвищення осмотичного тиску тощо [1]. Фаза проліферації розвивається з самого початку запалення поряд з явищами альтерації та ексудації, але стає переважаючою в більш пізній період процесу. Однією з умов прогресування проліферації є ефективність очищення вогнища запалення від пошкоджуючого агенту, мікроорганізмів, продуктів альтерації тканин, загиблих лейкоцитів



процесів, що запускає або прискорює біохімічні реакції в зоні запалення, де виник місцевий дефіцит власних протеолітичних ферментів, при якому збільшується тривалість запалення та затримується одужання. Протеолітичні ферменти не пригнічують запалення (оскільки це природна реакція організму на захворювання), а оптимізують його перебіг, створюють більш сприятливі умови його вирішення, будучи плацдармом для розгортання відновлювальних процесів. Під впливом протеаз відбувається мінімізація необхідної катаболічної фази запалення та прискорення регенеративної фази [2]. При пероральному прийомі протеолітичних препаратів відсутні побічні ефекти, характерні для парентерального застосування високоочищених кристалічних препаратів протеїназ
ЦЕ ЦІКАВО!!!
Понад 40 років в країнах Європи та Азії в клінічній практиці у терапії
запальних захворювань використовують серратіопептидазу — протеолітичний фермент природного
походження.
Вона міститься у всіх живих системах, але вперше була виявлена в кишечнику шовкопряда, який використовує її для розчинення кокона при появі метелика.
Німецький лікар Ханс Альфред Ніпер у своїй практиці назвав цей фермент «чудотворним», а Роберт Редферн, автор монографії про серратіопеп-
спричинені пластичною операцією; захворювання верхніх дихальних шляхів: зменшує в’язкість мокротиння та полегшує його виведення з дихальних шляхів;
знижує інтенсивність запалення завдяки гідролізу
біологічно активних речовин-медіаторів запалення (брадикініну, гістаміну, серотоніну тощо), зменшенню дилатації капілярів та регуляції їхньої проник-
ності;
блокує інгібітори плазміну і таким чином сприяє фібринолітичній активності останнього, розщеплює мікротромби фібрину, попереджає закупорку капілярів та сприяє розсмоктуванню ексудату, зменшенню набряклості та відновленню мікроциркуляції; знижує інтенсивність больового синдрому завдяки блокуванню вивільнення та гідролізу медіаторів
(брадикініну) у зоні запалення та зменшує подразнення
антибактеріальних препаратів у зоні запалення; пригнічує утворення мікроорганізмом біомембран, розщеплює складні елементи мокротиння, зменшує в’язкість секрету, полегшує відкашлювання, що сприяє покращенню проникності антибактеріальних засобів до зони запалення; працюючи синергічно з НПЗП та антибактеріальними засобами, сприяє посиленню їхньої позитивної дії.
Післяопераційний набряк та біль. В мультицентровому подвійному сліпому плацебо-контрольованого дослідженні M. Tachibana та співавт. щодо оцінки клінічної ефективності протизапального ферменту серратіопептидази (СЕРРАТА ), в якому взяли участь 174 пацієнтів після операції антротомії по КолдуеллуЛюку (Caldwell-Luc) у
на добу до операції, одноразово в ніч після операції та тричі на добу протягом 5 днів після операції; інші 86 пацієнтів отримували плацебо. У пацієнтів, які отримували серратіопептидазу
(СЕРРАТА®), порівняно з пацієнтами, які отримували
плацебо, вираженість набряку була значно меншою у кожній точці спостереження аж до 5-го дня після операції. Побічних ефектів при застосуванні ферментного препарату не зареєстровано [4]. У рамках рандомізованого проспективного дослідження Р.М. Esch та співавт. вивчили ефективність препарату у 66 пацієнтів, яким було виконано хірургічне втручання з приводу розриву латеральної зв’язки гомілковостопного суглоба внаслідок травми. У пацієнтів, які отримували серратіопептидазу (СЕРРАТА®), на 3-у добу після операції
прийомі серратіопептидази (СЕРРАТИ ) [6]. Лікування тунельного синдрому. A. Panagariya та A.K. Sharma провели попередню оцінку ефективності застосування серратіопептидази (СЕРРАТИ®) у 20 пацієнтів, що мали скарги на тунельний синдром, яким призначали серратіопептидази (СЕРРАТИ®) по 10 мг двічі на добу (з початковим коротким курсом німесуліду). Через 6 тижнів лікування у 65 % випадків відмічено значне клінічне покращення стану, яке також супроводжувалося покращенням електрофізіологічних параметрів. Істотних побічних ефектів не зареєстровано [7]. ЛОР-патологія. У багатьох дослідженнях встановлена здатність серратіопептидази (СЕРРАТИ ) змінювати реологічні властивості носового слизу у пацієнтів із хронічним синуситом. У рамках багатоцентрового подвійного сліпого плацебо-контрольованого дослідження A. Mazzone та співавт. вивчали ефективність серратіопептидази (СЕРРАТА®) в лікуванні 193 пацієнтів з гострими або
лікування [8].
ня та чинити відхаркувальну дію були продемонстровані як в експериментальних, так і клінічних дослідженнях [9–10].
У дослідженнях Y. Kase та співавт. на моделі бронхіту підтверджено муколітичну (експекторантну) активність серратіопептидази (СЕРРАТИ®), яка проявлялася
здатністю знижувати в’язкість мокротиння, а також
збільшувати кількість виділеного мокротиння [9].
S. Shimura і співавт. встановили, що пероральне застосування серратіопептидази (СЕРРАТИ®) пацієнтами з хронічною бронхолегеневою патологією має клінічно значущу муколітичну (експекторантну) дію в результаті прямого впливу на молекулярну структуру мокротиння [10].
Лактостаз. У рандомізованому подвійному сліпому контрольованому дослідженні W.H. Kee та співавт., в якому взяли участь 70 жінок з огрубінням молочних залоз, встановлено більш
1. Leuti A., Fazio D., Fava M., Piccoli A., Oddi S., Maccarrone M. (2020) Bioactive lipids, in ammation and chronic diseases. Adv Drug Deliv Rev., 159:133–169.
2. Деримедвідь Л. В., Вереітинова В. П. (2016) Комбіновані нестероїдні протизапальні засоби із серратіопептидазою у фармакотерапії запальних захворювань. Практикуючий лікар. 4 (5): 5–9.
3. Інструкція до застосування (СЕРРАТА®): https://mozdocs.kiev.ua/ likiview.php?id=22230
4. Tachibana M., Mizukoshi O., Harada Y., Kawamoto K., Nakai Y. (1984) A multi-centre, double-blind study of serrapeptase versus placebo in postantrotomy buccal swelling. Pharmatherapeutica, 3(8): 526–530.
5. Esch P.M., Gerngross H., Fabian A. (1989) Reduction of postoperative swelling. Objective measurement of swelling of the upper ankle joint in treatment with serrapeptase — a prospective study. Fortschr. Med., 107(4): 67–68, 71–72.
6. Al-Khateeb T.H., Nusair Y. (2008) E ect of the proteolytic enzyme serrapeptase on swelling, pain and trismus a er surgical extraction of mandibular third molars. Int. J. Oral Maxillofac. Surg., 37(3): 264–268.
7. Panagariya A., Sharma A.K. (1999) A preliminary trial of serratiopeptidase in patients with carpal tunnel syndrome. J. Assoc. Physicians India, 47(12): 1170–1172.
8. Mazzone A., Catalani M., Costanzo M., Drusian A., Mandoli A., Russo S., Guarini E., Vesperini G. (1990) Evaluation of Serratia peptidase in acute or chronic in ammation of otorhinolaryngology pathology: a multicentre, double-blind, randomized trial versus placebo. J. Int. Med. Res., 18(5): 379–388.
протягом 6 днів [12].
H. Aratani та співавтори вивчали концентрацію
ній стафілококовій інфекції ясен. Після попереднього введення серратіопептидази (СЕРРАТИ®) концентрація антибіотиків у яснах значно зростала, особливо в ділянці інфікованої ясна (осередку запалення) [13].
Koyama А. та співавт. доведено підвищення проникнення антибіотика (цефотіам) у тканини
L. Selan
9. Kasе Y., Seo H., Oyama Y., Sakata M., Tomoda K., Takahama K., Hitoshi T., Okano Y., Miyata T. (1982) A new method for evaluating mucolytic expectorant activity and its application. II. Application to two proteolytic enzymes, serratiopeptidase and seaprose. Arzneimittelforschung, 32(4): 374–378.
10. Shimura S., Okubo T., Maeda S., Aoki T., Tomioka M., Shindo Y., Takishima T., Umeya K. (1983) E ect of expectorants on relaxation behavior of sputum viscoelasticity in vivo. Biorheology, 20(5): 677–683.
11. Kee W.H., Tan S.L., Lee V., Salmon Y.M. (1989) e treatment of breast engorgement with Serrapeptase (Danzen): a randomised double-blind controlled trial. Singapore Med. J., 30(1): 48–54.
12. Okumura H., Watanabe R., Kotoura Y., Nakane Y., Tangiku O. (1977) E ects of a proteolytic-enzyme preparation used concomitantly with an antibiotic in osteoarticular infections. Jpn. J. Antibiot., 30(3): 223–227.
13. Aratani H., Tateishi H., Negita S. (1980) Studies on the distributions of antibiotics in the oral tissues: Experimental staphylococcal infection in rats, and e ect of serratiopeptidase on the distributions of antibiotics. Jpn. J. Antibiot., 33(5): 623–635.
14. Koyama A., Mori J., Tokuda H., Waku M., Anno H., Katayama T., Murakami K., Komatsu H., Hirata M., Arai T., et al. (1986) Augmentation by serrapeptase of tissue permeation by cefotiam. Jpn. J. Antibiot., 39(3): 761–771.
15. Selan L., Berlutti F., Passariello C., Comodi-Ballanti M.R., aller M.C. (1993) Proteolytic enzymes: a new treatment strategy for prosthetic infections? Antimicrob. Agents Chemother., 37(12): 2618–2621.
РОБОТ-ЩУПАЛЬЦЕ –
«Нашою метою було і залишається надання лікувальної допомоги з
мінімальними больовими відчуттями для пацієнта»
Джованні Піттільо, вчений-розробник робота-щупальця
Дослідники з Великобританії створили тонкого робота у вигляді щупальця, який можна спрямову-
вати всередину легень для огляду уражених ділянок. Вчені сподіваються, що новий пристрій допоможе
гностувати
Мініатюрний хірургічний робот, розроблений
грамується. Щупальце
заних циліндричних фрагментів довжиною близько 80 мм, які можуть рухатися незалежно один від одного.
Згідно з дослідженням, опублікованим командою з Лідса в журналі «Nature Communications Engineering», пристрій може проникати на 37% глибше, ніж стандартне обладнання, пошкоджуючи менше тканин, ніж у ході традиційного втручання. Дослідження щупальця проводилося з використанням бронхіальних дерев, надрукованих у 3D-форматі за анатомічними даними. Вчені збирають дані для початку
«Клієнтолюб»
Це нова система корпоративної культури мережі, яка працює з внутрішнім та зовнішнім клієнтами.
Основні її цінності — експертність, партнерство, емпатійність, інноваційність та успішність.
У компанії зазначили, що всі співробітники мають відчувати безпеку, підтримку своїх ідей та бути мотивованими працювати ще краще. Клієнти — емпатію та фахову допомогу фармацевта, щоб сучасні Простори здоров’я та краси працювали з турботою про кожного українця.
Любов до клієнта 8 липня руйнувань зазнала «Аптека Доброго Дня», яка знаходилась у сусідній будівлі з дитячою лікарнею «Охматдит». Фармацевти на місці безкоштовно забезпечували постраждалих кровоспинними, перев’язувальними матеріалами та антисептичними препаратами.
Аліна Нось, Аліна Льошенко, Анна Бурнус, Анастасія Афанас’єва, Дарія Данилюк, Олександр Подвинський та регіональний менеджер Ольга Ушенко одні з перших ринули на допомогу постраждалим.
У компанії зазначили, що сміливість та відданість роботі фармацевти проявляють щодня, адже працюють в умовах війни, під час обстрілів та блекаутів.
Підвищують кваліфікацію, отримують нові знання та навички, щоб надавати клієнтам більш професійну консультацію та проявляти до них емпатію.
Любов до співробітника
Щоб заохотити таких працівників, в «Аптеці Доброго Дня» вигадали подарункові бокси «Клієнтолюб», які фармацевти отримують за робочі досягнення та гарні відгуки відвідувачів.
Отити — це група розповсюджених запальних захворювань вуха, які значно погіршують якість життя людини і можуть привести до порушення слуху. Своєчасна діагностика та ефективне лікування отитів є важливим завданням охорони здоров’я.
Отити поділяють:
за перебігом — на гострі (тривалістю до 3–4 тижнів), підгострі (до 3 місяців) та хронічні (довше 3 місяців);
за етіологією — на інфекційні (вірусні, бактеріальні, грибкові), алергійні та травматичні;
залежно від локалізації запального процесу — на зовнішні, середні та внутрішні [1].
AІрина Кучма, кандидат медичних наук, доцент
Найбільш поширеним запальним
приблизно 30 % дітей переносить два чи більше епізодів
гострого середнього отиту з самого початку захворювання характерним
зовнішнього отиту, які розвиваються зазвичай впродовж 48 годин, такі:
виділення з вуха (слизисті або гнійні);
відчуття закладеності вуха та зниження слуху, що пов’язані з
набряком шкіри слухового проходу;
при дифузному зовнішньому отиті у 70 % випадків спостері-
гається біль (отальгія) різної інтенсивності, яка має постійний характер і посилюється при зміщенні вушної раковини, рухах
нижньої щелепи (розмові, жуванні) та натисканні на козелок; при фурункулі — біль може бути сильнішим і зменшується
при його розкритті чи хірургічному розтині; можливо підвищення температури до субфебрильних показників.
Діагностика зовнішніх отитів проводиться з урахуванням анамнезу, клінічного огляду та отоскопії. При отоскопії визначаються гіперемія, набряк, звуження та інфільтрація шкіри зовнішнього слухового проходу. Барабанна
бути
[3]. Для лікування
від збудника. Для зменшення
совують гліцерин-лідокаїнові вушні краплі.
випадків зовнішній отит піддається стандартному лікуванню, однак у деяких пацієнтів (хворих на діабет, СНІД, осіб, які
з ослабленим імунітетом) захворюваня відрізняється резистентністю до терапії, тяжким, рецидивуючим та хронічним перебігом. У таких хворих можливий розвиток злоякісного синьогнійного зовнішнього отиту з поширенням інфекції на хрящову та кісткову тканину. Такі пацієнти потребують госпіталізації з призначенням парентеральних антибіотиків [4]. Середній отит виникає
при інфекційних запаленнях носоглотки, коли збудник проникає в барабанну порожнину через євстахієву трубу. Немовлята сприйнятливіші до середнього отиту через
бактерії, які зумовлюють гнійний отит: Streptococcus pneumoniae (визначають у 40 % випадків), Haemophilus in uenzae (у 25 %), Мoraxella сatarrhalis (у 15 %), Streptococcus pyogenes та Staphylococcus aureus (у 10 %). Найчастіше інфекція проникає у середнє вухо ринотубарним шляхом і рідко (при скарлатині, кору, паротиті, краснусі, грипі) — через кров. Під впливом вірусів руйнується
війчастий епітелій слухової труби, що призводить до
порушення її евакуаційної функції. Поширенню інфекції у барабанну порожнину
сприяє чхання, кашель, неправильне висякування
носа (через обидві ніздрі, а не кожну по черзі), що підвищує тиск у носоглотці, внаслідок чого інфікований слиз форсовано долає бар’єр, яким і є слухова труба. При гострому середньому отиті також виникає реактивне запалення у повітроносних комірках соскопо-
дібного відростка [5].
Гострий середній отит зазвичай має три стадії перебігу:
гострий катаральний отит;
гострий гнійний отит; репаративний період.
Катаральну фазу викликають респіраторні
віруси, на цій стадії за рахунок імунного захисту організму патологічний процес може зупинитися і
самостійно усунутися. При приєднанні бактеріальної інфекції катаральний отит переходить у гострий
гнійний отит, який може перебігати зі спонтанною
перфорацією барабанної перетинки чи без перфорації (при своєчасному застосуванні антибактеріальних препаратів).
Симптоми гострого середнього отиту розвиваються дуже швидко, іноді впродовж 1–2 годин. При цьому одним з основних специфічних симптомів є сильний біль всередині вуха . До структур вуха, що мають рясну чутливу іннервацію, відносять барабанну перетинку, мукопериостеум барабанної порожнини та соскоподібного відростка. Біль при гострому середньому
Як розпізнати, що вушка болять у немовляти чи маленької дитини, яка не може пояснити, що з нею відбувається?
Маленькі діти реагуватимуть на біль криком, постійним сильним плачем, відмовою від годівлі. Дитина крутить або хитає головою, тягнеться рукою до враженого вушка, намагається притиснути його до
чи нахилити голову так, щоб хворе вушко було розташоване як можна нижче, прагне лежати на ураженому боці, що
гною). За ступенем тяжкості гострий середній
тривалістю більше 48 годин) та нетяжкий (температура до
менше 48 годин).
препаратами. При нетяжкій формі застосовують тактику уважного спостереження протягом 48–72 годин із призначенням антибіотиків в тих випадках, коли стан не поліпшується. Антибіотики призначаються відразу дітям до 6 місяців, при гострому гнійному отиті та тяжкій формі
рекомендаціями
Американської академії педіатрії та Американської
академії сімейних лікарів з діагностики та лікування цього захворювання, усунення болю є необхідним завданням терапії, особливо у перші 48 годин.
Найбільш ефективно та швидко усувають біль
вушні краплі з лідокаїном та феназоном. Їх комплексна дія передбачає вплив на усі компоненти виникнення оталгії: блокаду чутливих больових рецепторів, гальмування проведення больової імпульсації по периферичних нервах та протизапальний ефект для усунення джерела болю і відновлення пошкоджених тканин [7]. Місцеві засоби не слід
(в таких випадках проводять хірургічну тимпанопластику). У дітей наполегливий, млявий характер має алергічний середній отит, викликаний набряком у відповідь на дію алергенних факторів. Він виникає на тлі алергічної астми, вазомоторного риніту, екземи, дерматитів. У лікуванні використовують антигистамінні препарати та кортикостероїди.
протизапальні препарати [5, 6]. Баротравматичний отит викликається внаслідок різкого перепаду тиску в середньому вусі через швидку зміну тиску в навколишньому середовищі при пірнанні, дайвінгу, авіаперелітах. Відбуваються вібраційні порушення з баротравматичним набряком барабанної перетинки та іноді порожнини середнього вуха. У рідких випадках спостерігається розрив барабанної перетинки.
Симптоми баротравматичного отиту: різкий гострий біль у момент баротравми, що поступово зменшується
повідального підприємства протягом усієї 117-річної історії свого існування. Головною метою діяльності та розвитку КОМПАНІЇ «ЗДОРОВ’Я» є
створення й виведення на фармацевтичний ринок якісних і доступних препаратів. Основні вимоги, що висуваються до розроблюваних лікарських засобів — високі конкурентні переваги за фармакоекономічними показниками порівняно з оригінальними препаратами. На виробництві діють системи управління на базі вимог міжнародних стандартів GMP, ISO 9001: 2015, ISO 14001: 2015, HACCP Food Safety Systems.
Основна перевага перед конкурентами полягає в тому, що в портфелі
в 1 г якого міститься 10 мг лідокаїну гідрохлориду
ряду, який блокує потенціалзалежні натрієві
больових імпульсів нервовими волокнами. Анестезуюча дія лідокаїну розвивається дуже швидко (протягом декількох хвилин) та є у 2–6 разів сильнішою, ніж дія прокаїну.
місцевоподразнюючої дії. Феназон — нестероїдний протизапальний
похідний піразолону, який має анальгетичну та протизапальну дію завдяки здатності інгібувати синтез простагландинів. Комбінація феназону
09.04.2021 р. № 688 «Про затвердження Уніфікованого
лу первинної, вторинної (спеціалізованої) та третинної (високоспеціалізованої) медичної
Гострий середній отит» https://www.dec.gov.ua/mtd/ gostryj-serednij-otyt/
2. American Academy of Pediatrics Subcommittee on Management of Acute Otitis Media (2014) Diagnosis and management of acute otitis media. Pediatrics, 113(5): 1451–1465.
3. Настанова 00852. Зовнішній отит. Mervi Starck http://guidelines.moz.gov.ua/documents/ 2918?id=ebm00852&format=pdf
4. Rosenfeld R. M., Brown L., Cannon C. R. et al. Clinical practice guideline: acute otitis externa // Otolaryngol Head Neck Surg. 2018. Vol. 134 (4 Suppl). P. 4—23.
5. Bolt Penny, Barnett Peter, Babl Franz E, Lisa N. Sharwood. Topical lignocaine for pain relief in acute otitis media: results of a double-blind placebo-controlled randomised trial. Arch. Dis. Child. 2008 Jan; 93 (1): 40-4.
6. Foxlee R., Johansson A.C., Wejfalk J., Dooley L., Del Mar C.B. Topical analgesia for acute otitis media. Cochrane Data base of Systematic Reviews. 2016, Issue 3.
7. Hongzhuo Liua, Jinsong Haoa, Kevin S. Current strategies for drug delivery to the inner ear. Acta Pharmaceutica Sinica. 2019; 3(2): 86–96.
На день ніс продукує близько літра слизу, який містить ферменти і лейкоцити і допомагає зволожувати повітря, яке ми вдихаємо.
У носа є вії! Слизова носа вистелена війчастим (миготливим) епітелієм, війки якого затримують пил та інші частинки, не дозволяючи їм проникати в нижні дихальні шляхи. Ці вії разом із слизом, який їх вкриває —
перша лінія захисту організму від вірусів та алергенів. Захоплений віями шкідливий «матеріал» тоне в назальному слизу і як
по конвеєру, завдяки руху мікроскопічних
війок, поступово спускається до задньої стінки глотки, де проковтується та знешкоджується секретом шлункового соку.
Середньостатистична доросла людина щодня «проганяє»
поширеними є риновірус, аденовірус, вірус
та
парагрипу. Найбільш поширеними причинами бактеріального риносинуситу є Streptococcus pneumoniae (38 %), Haemophilus in uenzae (36 %) та Moraxella catarrhalis (16 %).
з ослабленим імунітетом. Фактори ризику розвитку риносинуситів
подразнюючих речовин, порушення анатомічної будови структур
та
носових пазух, захворювання, пов’язані з порушенням роботи мукоциліарного кліренсу (МЦК), інфекції верхніх дихальних шляхів, імунодефіцити, муковісцидоз, атопію, бронхіальну
частого епітелію, який
як «конвеєр». Основна функція війок — це синхронне коливання, що дозволяє проштовхувати слиз та інші частинки, які потрапили ззовні до глотки. Під дією холодного повітря, диму, судинозвужувальних крапель цей «конвеєр» порушується, і віруси та мікроби проникають у слизову оболонку, пошкоджуючи її. При порушенні цього механізму людина стає більш вразливою до інфекції. Так, проникнення та реплікація вірусів у клітинах слизової оболонки носа спричиняють їх загибель з вивільненням медіаторів запалення, що запускають каскад імунозапальних реакцій, а це, в свою чергу, призводить до втрати функціональної здатності війчастого епіте-
кліренс і спричиняє накопичення секрету. Тривале перенавантаження миготливого епітелію спричиняє його дистрофію та атрофію — «хибне коло» патогенезу риносинуситу замикається [1, 2, 3]. Клінічно риносинусит проявляється наступними симптомами [2]:
закладеність носа/ обструкція або виділення з носа (синдром переднього або заднього постназального затікання — post-nasal drip);
лицьовий біль/відчуття тиску;
спостерігається
набряк/
еритема; зміщення очного яблука;
двоїння в очах;
офтальмоплегія; зниження гостроти зору; інтенсивний головний біль; набряк у лобній ділянці;
симптоми нездужання, за рахунок ефективної роботи війкового епітелію, що забезпечує відновлення вільного носового дихання. В Україні згідно з «Уніфікованим клінічним протоколом первинної, вторинної (спеціалізованої) та третинної (високоспеціалізованої) медичної допомоги: гострий риносинусит» (Наказ МОЗ України від 13.10.2023 р. № 1793 «Про затвердження та впровадження медико-технологічних документів зі стандартизації медичної
ознаки сепсису, менінгіту; неврологічні
симптомів запалення навколоносових пазух, як головні болі, сльозотеча, а також від невралгій у ділянці обличчя. Hydrastis і Kalium bichromicum діють головним чином при
перебігу захворювання, що часто має місце при тривалому синуситі. Усі три інгредієнти сприяють зняттю набряку слизових
і відновленню носового дихання. Echinacea сприяє загальній під-
Cinnabaris
Kalium bichromicum
Hydrastis
Echinacea
дихання. Крім цього, в дослідженні
лікування як дуже добра у 99,4 % [7].
Friese K.H та Zabalotnyi D. I. (2007) у своєму подвійному, рандомізованому, сліпому, плацебо-контрольованому дослідженні, в якому взяли участь 144 пацієнти з гострим риносинуситом, провели вивчення ефективності та безпечності використання гомеопатичних засобів у лікуванні даного захворювання. Одержані результати свідчать, що у пацієнтів
в групі ЦИНАБСИН на 7-й день відмічалось значне, майже у 9 разів більше зниження загального сумарного балу симптомів риносинуситу в порівнянні з групою плацебо, а повне одужання зареєстровано 90,3 % пацієнтів в групі ЦИНАБСИН на 21-й день лікування, при цьому побічні ефекти не були зареєстровані [8].
У клінічному відкритому багатоцентровому дослідженні, в якому була проведена оцінка ефективності застосування ЦИНАБСИНУ у складі комбінованої терапії у хворих на гострий риносинусит, встановлена позитивна динаміка симптомів даного захворювання через 6 годин після призначення лікування у 28 %, а упродовж перших 2 діб — у 93 % пацієнтів. При цьому доведена безпечність запропонованого лікування задля оптимізації терапії риносинуситів як у дорослих, так і у дітей [9, 10]. Також активно вивчаються
ЦИНАБСИН. Показано, що він стимулює продукцію гамма-інтерферону, який, як відомо, має противірусні властивості, сприяє зниженню рівня прозапального інтерлейкіну-1β та підвищенню протизапального інтерлейкіну-10, таким чином гальмуючи запальні процеси. Отже, ЦИНАБСИН виявляє модулюючий вплив на активність різних ланок імунітету та має виражену протизапальну та противірусну дію [11].
НА ЗАМІТКУ!
ЦИНАБСИН — якість перевірена часом — лікарський засіб випускається в Німеччині з 1960 року, а в Україні — з 1997 року.
Містить у своєму складі натуральну унікальну комбінацію фармакологічно активних компонентів, які гармонійно доповнюють один одного
в лікуванні гострого та хронічного риносинуситу.
Ефективність та безпека доведена численними клінічними дослідженнями.
Як застосовувати таблетки ЦИНАБСИН? Таблетки приймати за 30 хвилин до їжі
ліками для усунення симптомів застуди, судинозвужувальними
2.
3.
С.Б., Джіров О.Р., Подовжній О. Г. Сучасний підхід до лікування гострого вірусного риносинуситу. Оториноларингологія. 2022. № 1-2 (5). С. 73–77.
4. Уніфікований клінічний протокол первинної, вторинної (спеціалізованої) та третинної (високоспеціалізованої) медичної допомоги: гострий риносинусит». Наказ МОЗ України від 13.10.2023 р. № 1793
5. Fokkens, W. J. et al. European Position Paper on Rhinosinusitis and Nasal Polyps 2020. Rhinology. 58(Suppl S29). P. 1–464.
6. Інструкція до застосування ЦИНАБСИНУ: https://mozdocs.kiev.ua/likiview. php? id=8183
7. Benchev R., Vicheva D. Treatment with Cinnabsin in patients with acute and exacerbated chronic rhinosinusitis. Romanian Journal of Rhinology. 2023. Vol. 13 (51).
8. Friese KH, Zabalotnyi DI. [Homeopathy in acute rhinosinusitis: a doubleblind, placebo-controlled study shows the efficiency and tolerability of a homeopathic combination remedy]. HNO. 2007;55(4):271-277. doi:10.1007/ s00106-006-1480-x.
9. Косаковський А. Л., Безшапочний С.Б. Про застосування
на гострий риносинуїт. Журнал вушних, носових і горлових хвороб. 2010. № 6. С. 2–6.
10. Безшапочний С.Б., Подовжній
Саме до таких компаній відноситься лідер фармацевтичного ритейлу України — мережа аптек «АНЦ». З
початку повномасштабної війни «АНЦ» перерахувала на благодійну допомогу понад 110 мільйонів гривень. Чи дійсно АНЦ має особливий підхід до благодійності, які проєкти підтримує компанія, як працює з
запитами та обирає партнерів, розповів СЕО мережі
аптек «АНЦ» Микола Щербина.
«Перш за все хочу наголосити, що
благодійність це не тренд, не мода, не
змагання «хто краще та більше». Це
щоденна робота. Почесна, відповідальна, важка. Благодійні ініціативи займають
важливе місце в діяльності
мережі аптек. «АНЦ» — є
для ЗСУ. Згодом ця ініціатива трансформувалась в окремий благодійний проєкт «Безплатні булер’яни та буржуйки для ЗСУ». На регулярній основі «АНЦ» співпрацює як з великими благодійними фондами та ініціативами («Повернись живим», «Благодійний Фонд Сергія Притули», UNITED24, RAZOM, Госпітальєри), так і закриває збори та запити окремих військових формувань. Лише з початку 2024 року компанія перерахувала більше 32 мільйонів гривень на потреби військовослужбовців, лікарень та представників вразливих верств населення.
каски, тактичні окуляри, берці, літня форма та тактичні рюкзаки вже отримано бійцями. «Найважливішими для нас — є люди! Дуже важливо підтримувати свою команду, щоб попри всю складність сьогоднішніх подій кожен був впевнений, що у нього є опора в особі «АНЦ». Ми пишаємось співробітниками, що стали на захист нашої країни. Чекаємо на повернення кожного!», — зазначив СЕО компанії Микола Щербина.
Цільовий запит на ліки та товари медичного призначення було отримано від начмедів підрозділів ЗСУ, де проходять службу співробітники мережі. Ця допомога переросла в масштабний проєкт «Ліки
офісу та за підтримки провідних фармкомпаній, було зібрано та відправлено на передову аптечки на сумму понад 8 мільйонів гривень. Партнерами ініціативи виступили такі провідні фармацевтичні компанії, як Дарниця, Інтерхім, Б.Браун Медікал Україна, Евітас, Київський вітамінний завод та корпорація Артеріум. «АНЦ» висловлює подяку всім, хто долучився до цієї важливої ініціативи.
Мережа аптек «АНЦ» активно бере участь у зборі коштів на безпілотні літальні апарати для військовослужбовців різних військових частин. У травні разом з БаДМ та OPTIVITA UKRAINE під об’єднанням «ФАР-
фонду «Сергія Притули», передала їх для лікарень на Сумщині, Харківщині, Запоріжжі та Миколаївщині. Раніше компанія також брала участь у зборі коштів на проєкти, зокрема на будівництво модульних будинків NEST та забезпечення ліками лікарень на деокупованих територіях. Регулярно «АНЦ» передає необхідні ліки для прифронтових лікарень та військових шпиталів, а також перераховує кошти на закупівлю важливих речей та продуктів для жителів прифронтових регіонів і переселенців.
Шановна
Федорівно,
щаблинки.
фармацевтичного училища і роботи в
аптеці в асистентській — до здобуття вищої фармацевтичної освіти у Національному фармацевтичному університеті і роботі завідувачкою аптеки. Згодом здобула другу
вищу освіту в рідній alma mater, яка впевнено, протягом
багатьох років є флагманом вітчизняної фармацевтичної
науки. Я ніколи не пожалкувала про вибір своєї професії, і в цьому завдячую флагману вітчизняної фармацевтичної
освіти — Національному фармацевтичному університету. Мені двічі пощастило, адже в роки мого навчання тут працював дуже яскравий професорсько-викладацький
Черних. А зараз на чолі з Аллою Анатоліївною
Громадський діяч — це не професія, а поклик серця і душі. Крім професіоналізму, тут важливі ще такі якості, як лідерство, ініціатива, вболівання за престижність професії, відданість своїй справі, небайдужість до проблем і питань, що, на жаль,
і народилася наша Асоціація, якій сьогодні уже десять років.
Не дивлячись на те, що Ваша Асоціація обласна, про неї знає вся фармацевтична спільнота України, представники аптечних мереж, виробників ліків, фармацевтичних навчальних закладів, громадських фармацевтичних асоціацій, органів виконавчої влади, місцевого самоврядування. Як вдалося досягти такого визнання?
З початку нашої діяльності ми разом з членами правління
до участі в роботі форумів, самітів, з’їздів, конференцій, семінарів, круглих столів, екзаменаційних комісій, обговорення освітніх програм. Асоціація фармацевтів «Кум Део» стала відома у фармацевтичному середовищі всіх областей України. Про нас також знають колеги з Індії, Польщі, Республіки Молдова, Швейцарії. Наші коментарі та інтерв’ю опубліковані як у галузевих, так і загальних ЗМІ, а пропозиції організації враховуються при ухваленні фармацевтичного законодавства України.
Яка основна мета і завдання Асоціації?
В умовах відсутності професійних спілок і монополізації приватного бізнесу у фармації, особливої актуальності набуває діяльність громадської професійної організації фармацевтів.
фармацевтичних
ку, підвищенні професійних компетенцій, впровадження принципів
цевтів України, залучення членів
до активної участі в роботі, міжнародна співпраця, удосконалення нормативно-правової бази.
У назві Асоціації є словосполучення «Кум Део», що стало своєрідним унікальним брендом. Чому саме така назва і з чим це пов’язано?
«Кум Део» — це латинський вислів, що означає «З богом!». Але зміст його набагато ширший, оскільки саме з такими словами у давнину аптекарі й монахи при монастирях безкоштовно видавали нужденним ліки, які готували власноруч. До того ж, на тогочасних рецептах лікарі розділяли назви призначених ліків такою собі решіточкою #, що
дження таких професійних, практичних проєктів, як: «Вінниччина фармацевтична — від давнини до сучасності», «Навчання впродовж всього життя», «Професійна школа фармацевта», «Фармацевти за чисте довкілля» та інші. Хочу наголосити, що це не одноразові події, а системно і комплексно продумані багаторічні заходи, які продовжуються і сьогодні і мають право на продовження,
університету, Інституту підвищення кваліфікації спеціалістів фарма-
аптечних мереж, досвідчені фармацевти, юристи. Щорічно до Дня фармацевтичного працівника України ми проводимо урочисті засідання фармацевтів. За нашим поданням нагороджується почесними грамотами, грамотами Обласної військової адміністрації та Обласної Ради, департаменту охорони здоров’я ОВА, міської Ради велика кількість кращих фахівців фармації.
Ми провели «Перший форум фармацевтів Вінниччини» з міжнародною участю в якому взяли участь більше п’ятисот фармацевтів. Наша Асоціація є членом громадської ради при Держлікслужбі України, громадської ради при Вінницькій обласній раді.
Ми опублікували біля сорока статей, інтерв’ю, дописів у професійних виданнях на актуальні професійні теми і питання, що сьогодні найбільше турбують фармацевтів. Провели десятки круглих столів, серед
свою місію на фармацевтичному фронті — донатять, волонтерять, надають фармацевтичну допомогу, співпрацюють з органами влади, військовими формуваннями, товариством Червоного Хреста, фондами, благодійними організаціями. Наша Асоціація ініціювала в області і підтримувала на рівні держави, особливо в прифронтових територіях і сільській місцевості ідею створення мобільних аптечних пунктів. Із залученням органів державної влади, представників територіальних громад, аптечних мереж, фармацевтів, і широкої громадськості ми провели круглий стіл про актуальність і необхідність забезпечення
населення лікарськими засобами на цих територіях саме через мобільні аптечні пункти. Фармацевти Вінниччини гідно представляли шостий, сьомий і восьмий з’їзди фар-
мацевтів України.
Що значить для Вас бути лідером фармацевтичної спільноти? І як Ви прокоментуєте свій вислів:
«Громадський діяч — це не професія, а поклик серця і душі»?
У будь-якій громадській організації має бути лідер, команда, ідея, мета, завдання і структура. Оскільки колеги довірили мені цю складну й відповідальну місію, я намагаюсь виправдати їхню довіру. Без високих слів хочу сказати, що потрібно просто любити свою професію, розуміти і підтримувати колег, не бути байдужим до справи, якій присвятив своє життя, бути ініціативним, творчим, відповідальним
здоров’я людей. Наша Асоціація — це неприбуткова організація, робота здійснюється на громадських засадах та
ентузіазмі, а це і є поклик серця і душі. Бажання передати свої знання колегам, підняти рівень, престижність, роль і значення професії фармацевта у суспільстві і є головними
мотиваторами нашої діяльності.
Відомо, що Асоціація проводить активну роботу з удосконалення нормативно-правової бази фармацевтичної діяльності. Які її
надзвичайно швидко змінюється. Нові технології
Тому приходиться ініціювати пропозиції щодо змін нормативно-правової бази, підштовхувати відповідні органи і структури, що є одним із завдань громадської організації.
Ми вносили пропозиції до Верховної Ради України, Міністерства охорони здоров’я України, Держлікслужби України,
посібник-довідник з питань актуальної нормативно-правової
останніх п’яти років в Україні широко обговорюється питання самоврядування у сфері охорони здоров’я. Наша асоціація не стоїть осторонь. Ми активно включилися у вивчення й обговорення законопроєктів, що були оприлюднені на сайтах Кабінету Міністрів України, МОЗ, таких було щонайменше п’ять. Ми провели три круглих столи, один спільно з Національним фармацевтичним університетом, опрацювали свої зауваження й пропозиції і надіслали до відповідних органів. Наша Асоціація в регіоні стала ініціатором й організатором обговорення цього питання. Ми долучали Громадську Раду при Вінницькій
Крім цього, ми висловили свою позицію стосовно цих
законопроєктів на сторінках «Щотижневика Аптека» у статтях «Фармацевтичне самоврядування — панацея, чи
об’єктивна необхідність часу», «І знову про фармацевтич-
не самоврядування».
Наша позиція однозначна: фармацевтичному самоврядуванню в Україні бути, і ми всіляко підтримуємо його розвиток. Адже у передових країнах Європи і світу, наприклад у Німеччині, Великій Британії і Польщі, вже давно впроваджене фармацевтичне самоврядування. Попри те, що процес впровадження фармацевтичного самоврядування в Україні складний і довготривалий, він дасть змогу кардинально змінити ситуацію в фармації на краще. Фахівці-фармацевти будуть мати змогу самостійно вирішувати багато професійних питань. Зокрема, допуск до професії, реєстр, ліцензування, навчання, соціальний захист, етичний кодекс фармацевта, відповідальність. А головне — покращити якість фармацевтичного забезпечення населення, підняти престижність, роль, місце і значення професії фармацевта у суспільстві, сформувати ставлення до аптеки не як до торгової точки, а як до повноцінного закладу охорони здоров’я, а до фармацевта — не як до продавця, а як до висококваліфікованого професіонала, який виконує свою основну місію — належної аптечної практики, фармацевтичної опіки, фармацевтичної послуги.
Багато заходів Ви проводите з міжнародною участю. Розкажіть, будь-ласка, з якою метою Ви долучаєте фахівців з інших країн?
Україна обрала шлях в Євросоюз, тому ми як фармацевти повинні орієнтуватися на кращі досягнення в галузі фармації,
Кишинів, ознайомилися з системою підготовки фармацевтичних
Така співпраця збагачує нас
та розкриває нові перспективи співробітництва у сфері фармацевтичної діяльності. Асоціація уже досягла певних здобутків, має визнання серед колег і фармацевтичної спільноти. А які подальші плани, наміри на майбутнє? Єдиним мірилом нашої діяльності є визнання
попереду багато планів і завдань. Наприклад, до Дня фармацевтичного працівника України ми організували Міжрегіональний форум фармацевтів з міжнародною участю та конкурс фармацевтів «Фармацевт — звучить гордо!» у п’яти номінаціях: кращий фармацевт, кращий асистент фармацевта, кращий клінічний фармацевт, кращий завідувач аптеки, кращий студент фармацевтичного навчального закладу. Плануємо системно проводити заходи у рамках наших проєктів, розширювати географію міжнародної співпраці, брати участь у професійних форумах, самітах, що організовують наші колеги, системно взаємодіяти з центральними і місцевими органами влади.
Ларисо Федорівно, що Ви побажаєте фармацевтам напередодні
c.47
c.54
Надійне джерело здоров’я та енергії для дорослих та малюків — вітаміни Доппельгерц®
c.60
Очні краплі «Хіло-комод» — незамінний помічник в лікуванні синдрому сухого ока
Продажі, що випереджають ринок: Farmak підбив підсумки 1 півріччя 2024 року
c.61
c.68
Гармонія у ритмі: Менорагін® для балансу менструального циклу
Аптечна мережа 9-1-1 — працює там, де людям найбільше потрібні ліки
Вітаміни (від лат. «vitа» — життя та «аmin» — речовина) — це низькомолекулярні органічні сполуки різноманіт-
ної хімічної структури, які необхідні для нормальної життєдіяльності організму. Вітаміни перебувають у складі ферментів, які прискорюють реакції метаболічних процесів організму та беруть участь у процесі
побудови й функціонуванні мембран клітин і клітинних структур. Зокрема, вітаміни необхідні для процесів росту, підтримки нормального кровотворення й статевої функції, нормальної діяльності нервової, серцево-судинної й травної систем, залоз внутрішньої секреції, продукуючих різні гормони, підтримки зору й нормальних властивостей шкіри [1].
із важливих причинних факторів, що веде до розвитку авітамінозу та зниження імунного захисту, є вірусні інфекції, зокрема, коронавірус. За даними Міністерства охорони здоров’я України, протягом трьох літніх місяців захворюваність на COVID-19 в Україні зросла майже в 13 разів. Тільки за серпень в країні зафіксували понад 25 тисяч випадків захворювання на коронавірус.
Виділяють наступні причини дефіциту
вітамінів [1]:
недостатнє споживання з їжею, виключення пев-
них груп продуктів (вегетаріанство, веганство та ін.);
підвищена потреба у вітамінах при посиленому рості у дітей, при вагітності, в період лактації;
гельмінтози, лямбліози та інші глистові інвазії;
дисбактеріоз кишечника;
інфекційні захворювання;
хронічні захворювання шлунково-кишкового тракту, цукровий діабет, хвороби печінки та щитоподібної залози, харчові алергії; перебування в умовах
виробництва серія ДОППЕЛЬГЕРЦ SYSTEM тепер
дитячого раціону харчування. ДОППЕЛЬГЕРЦ® КІНДЕР МУЛЬТИВІТАМІННИЙ КОМПЛЕКС містить у своєму складі 9 життєво-необхідних вітамінів (біотин, В6, В12 , D, E, C, фолієва кислота та пантотенат кальцію) та 4 мінеральних речовини (холін, хром, йод та цинк). Комплекс не містить консервантів та штучних барвників, що дуже актуально для дітей з високим ризиком розвитку алергічних реакцій.
Вітамінно-мінеральний комплекс ДОППЕЛЬГЕРЦ®
навантаженням, а також для тих, хто хоче завжди залишатися бадьорим
і енергійним та включає 13 життєво важливих
вітамінів, 8 мікроелементів та 4 мінерали, що сприяють підвищенню
до стресових ситуацій та несприятливих
факторів зовнішнього середовища.
ДОППЕЛЬГЕРЦ® АКТИВ ВІД А ДО ЦИНКУ випускається в двох формах: шипучих таблетках, яка сприяє більш швидкій насичуваності організму вітамінами та мінералами; таблетці-депо.
Забезпечення вітамінами, мінералами та мікроелементами часто не є оптимальним, якщо дієта незбалансована. Тіло може зберігати певні вітаміни та мінерали лише в обмеженій кількості. До них відносяться такі водорозчинні вітаміни,
та інших факторів імунітету; забезпечує нормальну діяльність зорового аналізатора, бере участь у синтезі зорового пігменту та сприйняття
оком світла; є необхідним для підтримки та відновлення тканин епітелію. Ретинол прискорює процес
загоєння, а також стимулює синтез колагену, знижує
ризик приєднання вторинної інфекції, бере участь в
окисно-відновлювальних процесах, регуляції синтезу
білків, сприяє нормальному обміну речовин, функції
клітинних та субклітинних мембран, є необхідним
для росту нових клітин, уповільнює процес старіння.
Вітамін А захищає мембрани клітин мозку від руйнівного впливу вільних радикалів. Вітамін Н (біотин) — входить до складу ферментів, що регулюють білко-
опорно-рухового
синтез елементів
тканини. Вітамін В1 захищає мембрани клітин від токсичної дії продуктів перекисного окислення, виступаючи як антиоксидант та імуностимулятор.
Вітамін В2 (рибофлавін) — бере участь у синтезі глутатіону — потужному антиоксиданту, сприяє активації заліза, фолієвої кислоти і вітамінів B1, B3 і B6. Вітамін В6 (піридоксину гідрохлорид) — бере участь у метаболізмі білків, синтезі ней ромедіаторів центральної і периферичної нервової системи, виробленні енергії, стимулює синтез гемоглобіну в еритроцитах, сприяє руйнуванню шкідливого
Вітамін С (аскорбінова кислота) — бере участь в утворенні колагену, серотоніну з триптофану, катехоламінів, синтезі кортикостероїдів. Аскорбінова кислота також бере участь у перетворенні холестерину на жовчні кислоти. Вітамін С необхідний для детоксикації у гепатоцитах за участю цитохрому P450; сам нейтралізує супероксидний радикал до перекису водню. Аскорбінова кислота стимулює синтез інтерферону, отже, бере участь у імуномодулюванні. Вітамін С покращує всмоктування заліза з їжі шляхом перетворення іону заліза, гальмує глікозилювання гемоглобіну та перетворення глюкози на сорбіт.
Вітамін D — забезпечує нормальний ріст та розвиток кісток, попереджає розвиток рахіту та остеопорозу шляхом регуляції мінерального обміну; сприяє
м’язовому тонусу, підвищує імунітет, необхідний для функціонування щитовидної залози та нормальної зсідання крові; допомагає організму відновлювати захисні оболонки, що оточують нерви; бере участь у регуляції артеріального
травмах;
до аеробних навантажень і стимулює вироблення енергії, захищає клітини від окисного ушкодження; нормалізує рухову функцію шлунково-кишкового тракту та роботу м’язів; має протизапальну та імуномодулюючу активність. Вітамін К бере участь в синтезі сфинголіпідів, що входять до складу мембран нервових клітин і оболонок нервових волокон.
Нікотинамід — бере участь в енергозабезпеченні клітин і в знешкодженні шляхом окиснення природних та чужорідних речовин.
Вітамін В5 (пантотенова кислота) — знижує рівень LDL, підтримуючи рівень холестерину в нормальному діапазоні, додатково сприяє зниженню артеріального тиску за рахунок вазодилатації.
Кальцій — необхідний для нормального утворення кісткової тканини, формування зубів, процесу зсідання крові,
функції еритроцитів, участі в утворенні соляної кислоти шлункового соку, активації амілази, знешкодженні продуктів патологічного розпаду тканин. Хром — регулює синтез РНК і ДНК, бере участь в підтримці балансу глюкози в крові, сприяє поповненню запасів глікогену, забезпечує зниження апетиту.
Залізо — відповідає за транспорт кисню в організмі, входить до складу ферментів-цитохромів, бере участь в усіх детоксикаційних процесах. Йод — забезпечує нормальну роботу
мозку та відповідає за здатність до концентрації уваги.
Калій — необхідний для правильного функціонування серця і системи кровообігу, допомагає підтримувати адекватні кров’яний тиск та м’язовий тонус.
Мідь — сприяє росту і розвитку, бере участь у кровотворенні, імунних реакціях, перетворенні заліза організму в
гемоглобін. Марганець — необхідний для нормального засвоєння вітаміну В1 та функціонування вітаміну К, бере участь в
обміні аскорбінової кислоти, енергетичному обміні, процесах формування
кислотно-лужного балансу, зберіганні генетичної інформації. Селен захищає організм від токсичних мінералів, таких як миш’як, кадмій, ртуть та свинець, є складовою метаболізму простагландинів, які контролюють запальний процес.
Кремній — необхідний для процесів мінералізації кісткової тканини, синтезу колагену, позитивно впливає на стан шкіри, волосся і нігтів, сприяє попередженню атеросклерозу і хвороби Альцгеймера.
Цинк — бере участь практично в усіх обмінних процесах в організмі. Разом з вітамінами А, Е, С та селеном цинк утворює антиоксидантний комплекс, який підвищує опірність організму до інфекцій.
Холін — це структурний компонент нервової системи. Необхідний для синтезу важливого нейромедіатора — ацетилхоліну та основних компонентів кліткових мембран. Холін сприяє переробленню, розрідженню, транспортуванню та
Література:
1. Tardy A. L., Pouteau E., Marquez D. et al. Vitamins and Minerals for Energy, Fatigue and Cognition: A Narrative Review of the Biochemical and Clinical Evidence. Nutrients. 2020. Vol. 12 (1). P. 228.
2. https://www.doppelherz.ua
3. Biesalski H. K, Tinz J., Metrics P. X. Multivitamin /mineral supplements: Rationale and safety — A systematic review. Nutrition. 2017. Vol. 33. P. 76–82.
4. Blumberg J.B., Bailey R. L., Sesso H. D., Ulrich C. M. e evolving role of multivitamin / multimineral supplement use among adults in the age of personalized nutrition. Nutrients. 2018. № 10 (2). Р. 248.
1. Назвіть можливі причини дефіциту вітамінів в організмі:
a. Тривале застосування антибіотиків.
b. Інфекційні захворювання.
c. Фізичне та нервове перенавантаження.
d. Дисбактеріоз кишечника.
e. Всі відповіді вірні.
2. Які вітаміни є ключовими при зниженій опірності організму
з огляду на те, що їх прийом веде до покращення імунного захисту? (декілька варіантів)
a. Фолієва кислота.
b. Рибофлавін.
c. Вітамін К.
d. Вітамін С.
e. Пантотенова кислота.
3. Які кислоти входять до складу омега-3 жирних кислот? (декілька варіантів)
a. Докозагексаєнова.
b. Ейкозапентаєнова.
c. Пантотенова.
d. Дезоксирибонуклеїнова.
4. Які основні фармакологічні ефекти притаманні омега-3
поліненасиченим жирним кислотам, що входять до складу «ДОППЕЛЬГЕРЦ® KINDER ОМЕГА-3»?
a. Покращують когнітивні здібності.
b. Знижують рівень холестерину, попереджаючи розвиток
атеросклерозу.
c. Беруть участь в синтезі родопсину.
d. Впливають на процеси формування кісток і зубів.
5. Які фармакологічні ефекти притаманні аскорбіновій
кислоті, що входить до складу вітамінно-мінеральних
дієтичних добавок «ДОППЕЛЬГЕРЦ®»? (декілька варіантів)
a. Антиоксидантний.
b. Антимікробний.
c. Імуномодулюючий.
d. Антианемічний.
e. Знеболювальний.
6. Які життєво важливі вітаміни входять до складу «ДОППЕЛЬГЕРЦ® КІНДЕР МУЛЬТИВІТАМІННИЙ КОМПЛЕКС»? (декілька варіантів)
a. Тіамін (вітамін В1).
b. Біотин (вітамін В7).
c. Аскорбінова кислота.
d. Вітамін К.
e. Піридоксин (вітамін В6).
7. Яка роль холіну, що входить до складу дієтичної добавки «ДОППЕЛЬГЕРЦ® КІНДЕР МУЛЬТИВІТАМІННИЙ КОМПЛЕКС»? (декілька варіантів)
a. Необхідний для синтезу ацетилхоліну.
b. Бере участь в метаболізмі ліпідів.
c. Регулює процеси мінералізації кісток.
d. Підтримує кислотно-лужний баланс.
e. Є структурним компонентом нервової системи.
8. Які життєво важливі вітаміни входять до комплексу «ДОППЕЛЬГЕРЦ® АКТИВ ВІД А ДО ЦИНКУ»?
a. Вітамін К.
b. Вітамін С.
c. Пантотенова кислота.
d. Ціанокобаламін.
e. Всі відповіді вірні.
9. Які переваги має таблетка-депо «ДОППЕЛЬГЕРЦ® АКТИВ ВІД А ДО ЦИНКУ» над звичайною таблетованою лікарською формою? (декілька варіантів)
a. Забезпечує повільне вивільнення поживних речовин. b. Швидко елімінується із організму.
c. Оптимальне засвоєння необхідних вітамінів протягом доби за рахунок поступового вивільнення компонентів.
d. Викликає надмірну фізичну та розумову діяльність.
e. Не викликає небажаних побічних реакцій.
10. Кому може бути рекомендована дієтична добавка «ДОППЕЛЬГЕРЦ®
a. Людям, які ведуть активний спосіб життя.
b. Особам, що скаржаться на надмірне фізичне чи розумове навантаження.
c. Задля підвищення опірності організму в період інфекцій.
d. У разі дієтичного харчування.
e. Всі відповіді вірні.
«ХІЛО-КОМОД»
незамінний
і розваги тісно пов’язані з гаджетами і цифровими технологіями, при цьому часто страждає зір. Синдром сухого
ока можна віднести до «хвороб цивілізації», що пов’язані з науковотехнічним прогресом. За даними ВООЗ, кожного року близько 300 мільйонів людей скаржаться на погіршення
зору, з них майже 30 %
дорослого населення страждають саме на синдром сухого ока. Ця
Термін «комп’ютерний
асоціацією оптометристів і вважається професійним захворюванням.
Головною причиною виникнення комп’ютерного синдрому є тривала фіксація погляду на монітор пристрою (телефона, ноутбука, комп’ютера), внаслідок чого різко зменшується кількість моргальних рухів повік (за оцінками дослідників, моргання зменшується в 10–15 разів). Людина настільки сконцентрована на своїй роботі, що не може контролювати частоту моргання. Як результат, очна щілина довго залишається відкритою, що веде до швидкого пересихання очної поверхні внаслідок порушення слізної плівки. Через відсутність слізної рідини у першу чергу страждає рогівка, що
зору. Згодом виникає почервоніння очей внаслідок розширення кон’юнктивальних судин. Отже, головною небезпекою
Крім того, виділення сльози може тимчасово порушуватися після офтальмологічних операцій [2]. По-друге, є чинники способу життя й навколишнього середовища, котрі впливають на те, наскільки інтенсивно випаровується сльозова плівка: постійна робота перед комп’ютерним або іншими моніторами;
багатогодинне керування автомобілем;
перебування в приміщенні з сухим повітрям (через кондиціонування або опалення);
перебування на відкритому повітрі під впливом ультрафіолету і/або сильного вітру;
носіння контактних лінз; використання антибактеріальних офтальмологічних препаратів [2].
Синдром сухого ока проявляється різними скаргами:
біль в очах;
відчуття піску в очах;
різь в очах;
свербіж та почервоніння очей;
погіршення зору;
відчуття постійного подразнення очей; відчуття сухості очей
наявність у складі лише натуральних речовин (зокрема, гіалуронова кислота);
мінімальна кількість або відсутність побічних
ефектів, гіпоалергенність;
відповідна осмолярність розчину (275–316 мОсм/л);
«ХІЛО-КОМОД» — ДБАЙЛИВИЙ
Найважливішою складовою очних крапель «ХІЛО-КОМОД» є гіалуронова кислота (ГК) — природний полімер, який міститься в клітинному просторі багатьох біологічних структур і рідинах організму організму людини (зокрема, і в слізній рідині). ГК допомагає утримувати вологу у різних ти-
пах тканин людського організму, і навіть на поверхні очей. До того ж, натрію гіалуронат бере участь у регенерації різних тканин організму. Завдяки вираженим гідрофільними властивостями,
можливе поєднання з постійним використанням контактних лінз; наявність безпечного цитратного буфера; зручний флакон для застосування.
Очні краплі «ХІЛО-КОМОД» виробництва фармацевтичної компанії «URSAPHARM Arzneimittel GmbH» (Німеччина) відповідаюсь усім зазначеним вимогам [4].
Очні краплі «ХІЛО-КОМОД» 0,1% розчин гіалуронової кислоти РП UA/7443/01/01
Відпускається без рецепта
Показання до застосування: симптоматичне лікування сухості рогівки та конʼюктиви (синдром сухих очей) [9].
ГК є ідеальним рішенням для очних крапель. Саме ця концентрація ГК створює необхідну в’язкість розчину, що допомагає штучній сльозі довше залишатися на очній поверхні, не випаровуватися, покращувати стабільність слізної плівки [5, 6].
Проведені дослідження щодо застосування препарату на основі 0,1 % розчину ГК («ХІЛО-КОМОД») у пацієнтів із синдромом сухого ока після ексимер-лазерної хірургії (LASIK, LASEK) різних порушень рефракції. Було доведено, що використання 0,1 % розчину ГК після LASIK покращує якість слізної плівки,
є застосування цитратного буфера у розчинах ГК. Цитрат, на відміну від фосфату, не утворює важкорозчинних сполук (кальцію фосфат). Буферна система, що містить іони цитрату, діє як хелатний агент, здатний зберегти кальцій у розчиненому вигляді. Доведено, що очні краплі, які містять цитрат, володіють репаративними властивостями, які ґрунтуються на придушенні інфільтрації запаленої тканини рогівки поліморфноядерними лейкоцитами [4].
Отже, для кращої безпеки й переносимості сльозозамінної терапії сухості очей слід віддавати перевагу засобам із цитратним буфером без консервантів. Саме «ХІЛО-КОМОД» не містить фосфатів та консервантів [4].
Суттєвою перевагою очних крапель «ХІЛОКОМОД» є покращена сучасна
система, що забезпечує стерильність розчину без необхідності включення до складу консервантів, — система COntinuous MOno Dose — COMOD. Ця технологія дозволяє точно дозувати розчин, що суттєво знижує зайву витрату крапель. При натисканні на помпу з’являється тільки одна крапля, що забезпечує економне використання, а також запобігає контакту розчину, що знаходиться у флаконі, з навколишнім повітрям. Це дозволяє застосовувати очні краплі з одного флакона протягом тривалого часу (до 6 місяців).
[9]
Оскільки «ХІЛО-КОМОД» не містить консервантів, він добре переноситься навіть при тривалому застосуванні. У вкрай поодиноких випадках повідомлялося про розвиток реакцій гіперчутливості, таких як подразнення, відчуття печіння, почервоніння, біль, свербіж, набряк повік або сльозотеча, які зникали одразу після припинення застосування препарату [9]. Фармацевтична опіка в аптеці передбачає консультування відвідувачів щодо способу застосування ліків. За
«ХІЛО-КОМОД»
рекомендовано застосовувати по 1 краплі
тричі на добу в кожне око. За необхідності
кількість застосувань можна збільшити до 10 разів на добу. Важливою особливістю препарату є те, що він повністю сумісний із носінням контактних лінз [9].
ПЕРЕВАГИ «ХІЛО-КОМОД»: Флакон-крапельниця запатентованої
1. https://www.ursapharm.de/en/systems-and-production/comod-system/ 2. https://www.edqm.eu. Certi cate of suitability No. R1-CEP 2001-385-Rev 07
Список літератури:
1. John R. Hayes., James E. Sheedy, Joan A. Stelmack, Catherine A. Heaney «Computer use, symptoms, and quality of life». Optom Vis Sci. 2007; 84(8): 738–44.
2. Zemanová M. Dry eye disease. A review. Cesk Slov O almol. 2021;77(3):107–119.
3. Bernauer W, iel MA, Kurrer M, Heiligenhaus A, Rentsch KM, Schmitt A, Heinz C, Yanar A. Corneal calci cation following intensi ed treatment with sodium hyaluronate arti cial tears. Br J Ophthalmol. 2006;90(3):285-8.
4. Косуба С.І., Тутченко Л.П., Туманова О.В., Сковрон М.В. Вплив буферних систем і консервантів у складі очних крапель на безпечне й тривале лікування пацієнтів із хворобою сухого ока. Архів офтальмології України. 2019;3(7).
5. Pinheiro R, Pan l C, Schrage N, Dutescu RM. e Impact of Glaucoma Medications on Corneal Wound Healing. J Glaucoma. 2016;25(1):122-7.
6. Labiris G. Impact of 0.1 % sodium hyaluronate and 0.2 % sodium hyaluronate arti cial tears on postoperative discomfort following cataract extraction surgery: a comparative study. Eye Vis (Lond). 2019;6:6.
7. Wu Y, Xu L, Song Y, Zhang Q, Qin G, Yang L, Ma J, Palme C, Moore JE, Pazo EE, He W. Management of Post-LASIK Dry Eye with Intense Pulsed Light in Combination with 0.1 % Sodium Hyaluronate and Heated Eye Mask. Ophthalmol er. 2022 Feb;11(1):161-176.
8. Ntonti P, Panagiotopoulou EK, Karastatiras G, Breyannis N, Tsironi S, Labiris G. Impact of 0.1% sodium hyaluronate and 0.2% sodium hyaluronate arti cial tears on postoperative discomfort following cataract extraction surgery: a comparative study. Eye Vis (Lond). 2019 Feb 11;6:6.
9.
Надсилайте
Ваші творчі роботи
Про особливості застосування і
переваги очних крапель
«ХІЛО-КОМОД» дізнавайтесь зі статті "
«ХІЛО-КОМОД» – незамінний
помічник в лікуванні синдрому сухого ока", що опублікована у журналі «Сучасна фармація»
https://www.modern-pharmacy.com.ua
Farmak підбив підсумки 1
Провідний виробник ліків в Україні Farmak відзвітував про підсумки першого півріччя 2024 року. За цей період компанія досягла значного зростання: продажі в аптеках збільшилися на 20 %, а категорія «госпіталь» показала приріст у 42 %. Такі показники вкотре підтверджують стійке лідерство Farmak на українському фармацевтичному ринку. гічних втручаннях і діагностичних процедурах, пре-
18 % у гривні в роздрібній торгівлі відносно
6 місяців 2023 року. Госпітальні закупівлі
збільшилися на 6,3 % за аналогічний період.
І я не можу не відмітити те, що Farmak
зростав у цей період швидше за ринок.
Більш того, ми зростали і у прямому
сенсі: придбали польську компанію Symphar. Таке розширення дозволить нам
прискорити міжнародну експансію, яку Farmak розгорнув ще до початку великої
війни», — зазначив генеральний директор
компанії Володимир Костюк.
Команда Farmak за шість місяців 2024 року встигла також випустити на ринок 5 нових лікарських засобів. Це ліки для загальної анестезії,
Фінансовий успіх компанії
перше півріччя цього року Farmak сплатив до державного бюджету 687,5 млн грн податків.
Крім того, разом із Благодійним фондом Родини Жебрівських* компанія спрямувала 78,2 млн грн на підтримку армії. Загалом, з початку повномасштабного вторгнення, сумарний обсяг допомоги від Farmak та фонду на потреби ЗСУ та гуманітарну підтримку перевищив 258,8 млн грн. Наразі Farmak експортує свою продукцію до близько 60 країн світу, зокрема ЄС, Азії, Центральної та Південної Америки, до Близького Сходу, а також до Австралії. Компанія має представництва в Узбекистані, Казахстані, Киргизстані та В’єтнамі та маркетингові компанії в Польщі, ОАЕ, Швейцарії, Сполученому Королівстві, а також у Чехії та Словаччині та незабаром
циклічних змінах функції статевої системи. Крім цього, одночасно виникають циклічні коливання функціонального стану й інших систем жіночого організму: серцево-судинної, нервової, ендокринної. Менструальний цикл
доби менструації, що наступила, до першої доби наступної менструації. Зазвичай цей цикл триває від 21 до 35 днів, але може варіюватися залежно від індивідуальних особливостей організму жінки. Серед органів репродуктивної системи найбільш виражені циклічні зміни спостерігаються в яєчниках та матці. Основною їх особливістю є двофазність, яка обумовлена циклічними змінами функції яєчників: фазою дозрівання фолікула з наступною овуляцією та фазою жовтого тіла. Нормальний менструальний цикл включає в себе три основних компоненти: циклічні зміни в системі гіпоталамус-гіпофіз-яєчники (яєчниковий цикл), циклічні зміни




Поступове підвищення естрогенів в організмі в фолікуліновій фазі яєчникового циклу сприяє гіпертрофії клітин біометрію. У лютеїновій фазі циклу під впливом прогестерону виникає гіперплазія клітин. Найбільш виражені зрушення протягом циклу виникають в функціональному шарі ендометрію, який складається із залоз, що виділяють слиз, і епітелію. В ендометрії під час менструального циклу настають зміни в епітеліальних клітинах, стромі і судинах. Залежно від фази яєчникового циклу — фолікулінової чи лютеїнової — в ендометрії розрізняють фази проліферації і секреції. Якщо запліднення не відбулось, то
фаза — десквамація
десквамації, яка спостерігається під час менструації, до початку росту ендометрію. Десквамація закінчується
Після цього в результаті
продовжується 3–4 доби [1]. Фаза секреції — це
десквамацією всього функціонального шару ендометрію. Звичайно кількість менструальної крові коливається від 50 до 150 мл. За складом вона значно відрізняється від крові, яка циркулює в організмі. У ній більше води (біля 85 %), але менше еритроцитів і лейкоцитів. Менструальна кров не містить тромбіну,
і тому не згортається. Приблизно четверта
препаратів, зокрема, протизаплідних чи засобів для лікування хвороб щитоподібної залози, найчастіше викликає гормональний збій та затримку місячних.
Симптоми, які характеризують порушення
менструального циклу:
швидка втомлюваність, погане самопочуття;
маткові кровотечі в середині циклу;
підвищена дратівливість;
больові відчуття в попереку та внизу живота, особливо в першу добу місячних;
різке коливання маси тіла;
нудота, блювота, стрімкі перепади
тиску; Підходи
Гормональна терапія. Використання оральних контрацептивів або інших гормональних
для регуляції менструального циклу та зменшення симптомів, таких як біль та надмірна кровотеча.
Лікування основного захворювання. Якщо порушення менструального циклу є наслідком основного захворювання (порушення щитоподібної залози тощо).
Регуляція ваги.
Збалансоване харчування.
Фізична активність.
— надмірну менструальну крововтрату, яка порушує фізичний стан, соціальне, емоційне та навіть матері-
Основною метою в корекції розладів менструального циклу є
рецидивів шляхом нормалізації менструального циклу. Для цього використовується
самопочуття.
Дієтична добавка на рослинній основі МЕНОРАГІН® (українська фармацевтична компанія «ЗДРАВО») — єдиний в Україні фізіологічний гемостатик для дбайливої корекції менорагій у жінок репродуктивного віку та для забезпечення повноцінної якості життя жінки у критичні дні.
Активними інгредієнтами МЕНОРАГІНУ® є:
екстракт грициків (Сapsella bursa pastoris) — 200 мг;
екстракт листя кропиви дводомної (Urtica dioica) — 50 мг;
екстракт деревію звичайного (Achillea milefolium) — 50 мг; L-метилфолат кальцію — 150 мкг [5].
МЕНОРАГІН® — унікальна комбінація фітоекстрактів та L-метилфолату кальцію — безпечна до застосування, оскільки не спричиняє небажаних побічних реакцій з боку серцево-судинної
Екстракт грициків (Сapsella
у разі менорагії
походження (менструальні й позаменструальні маткові кровотечі), може сприяти покращенню скорочувальної діяльності гладкої мускулатури матки та зменшенню больових відчуттів, пов’язаних з менструацією, володіє протизапальною та кровоспинною активністю, знижує проникність капілярів, артеріальний тиск, виявляє антиоксидантну активність. Екстракт листя кропиви дводомної (Urtica dioica) проявляє знеболювальну та протизапальну активність, покращує скорочувальну активність матки, сприяє зниженню артеріального тиску за рахунок розширення периферійних
на жаль, стають причиною близько 50 % всіх операцій з видалення матки; за результатами соціологічних опитувань, маткові кровотечі порушують нормальний ритм життя кожної пʼятої жінки, їм доводиться пропускати важливі події, обмежувати спорт, не завжди встигати з роботою.
важною природною формою фолатів
формою в плазмі людини. Фолати беруть участь у формуванні клітин крові, зокрема, еритроцитів; обміні гомоцистеїну, що в свою чергу позитивно впливає на згортальну функцію крові; синтезі амінокислот, ДНК та РНК; сприяє відновленню тканин. Споживання достатньої кількості фолатів позитивно впливає на підтримку нормального психоемоційного стану, запобігає перепадам настрою, депресії та тривожності, сприяє нормалізації сну за рахунок участі у синтезі нейротрансмітерів. МЕНОРАГІН® рекомендовано застосовувати жінкам віком від 12 років як додаткове джерело екстрактів лікарських рослин та метилфолату (у вигляді L-метилфолату кальцію) у комплексній терапії
нормалізації функціонування кровотворної
судинної систем, підтримки організму,
кровоспинний ефект при рясних місячних;
оптимальна комбінація фітоекстрактів для стабілізації менструального циклу;
безпека в застосуванні (відсутність тромбозів);
зручний, короткий курс прийому — 5 днів.
Порушення менструального циклу — це проблема, яка може суттєво впливати на якість життя жінки. МЕНОРАГІН® відкриває нові можливості для ефективної та безпечної
1. Hennegan J et al. Menstrual health: a de nition for policy, practice, and research. Sex. Reprod. Health Matters. 2021. № 29: 1911618.
2. Munro M.G., Critchley H.O., Broder M.S., Fraser I.S.«FIGO Working Group on Menstrual Disorders. FIGO classi cation system (PALM-COEIN) for causes of abnormal uterine bleeding in nongravid women of reproductive age.» Int J Gynaecol Obstet. 2011 Apr;113(1):3-13. 3.
Ukr. Journal Health of Woman. 2024. № 2(171):5-11. 4.
1. Які розлади менструального циклу пов’язані з рясними місячними?
a. Дисменорея.
b. Альгодисменорея.
c. Гіперменорея.
d. Гіпоменорея.
e. Менорагія.
f. Аменорея.
2. Вкажіть прояви, що характерні для розладів менструального циклу? (декілька варіантів)
a. Загальна слабкість, втомлюваність, підвищена дратівливість.
b. Больові відчуття в попереку та внизу живота.
c. Рясні менструальні кровотечі.
d. Болі в ділянці епігастрію.
e. Затримка менструації до 2 діб.
3. Що характерно для аномального менструального циклу?
(декілька варіантів)
a. Тривалість менструальної кровотечі 8 діб та більше.
b. Тривалість менструальної кровотечі до 5 діб.
c. Тривалість циклу від 24 до 38 діб.
d. Обʼєм менструальної крововтрати понад 80 мл.
4. Альтернативним методом корекції та профілактики тяжкої менструальної кровотечі на тлі прийому гормональних контрацептивів є:
a. Використання фітотерапевтичних препаратів.
b. Використання гемостатичних лікарських засобів.
c. Корекція і профілактика не рекомендовані.
d. Практики релаксації.
5. Які рослинні компоненти входять до складу дієтичної добав-
ки МЕНОРАГІН®? (декілька варіантів)
a. Екстракт листя кропиви дводомної.
b. Екстракт грициків.
c. Екстракт ромашки.
d. Екстракт деревію звичайного.
e. Екстракт водного перцю.
6. Яким ефектом володіє екстракт грициків, що входить до складу дієтичної добавки МЕНОРАГІН®? (декілька варіантів)
a. Впливає на обʼєм та тривалість маткової кровотечі.
b. Сприяє покращенню скорочувальної діяльності гладкої мускулатури матки.
c.
d. Впливає
7.
b.
c.
крововтрати.
d. При дисменореї.
e. Всі відповіді правильні.
8. Для якого із компонентів дієтичної
характерне прискорення згортання крові за рахунок прямого впливу на синтез протромбіну?
a. Екстракт листя кропиви дводомної.
b. Екстракт грициків.
c. Екстракт деревію звичайного.
d. L-метилфолат кальцію.
9. Які переваги L-метилфолату кальцію, що входить до складу дієтичної добавки МЕНОРАГІН®, над фолієвою кислотою? (декілька варіантів)
a. Більш значною мірою підвищує концентрацію фолату в еритроцитах.
b. Краще засвоюється.
c. Значно краще елімінується.
d. Бере участь у синтезі нейромедіаторів.
e. Бере участь в обміні гомоцистеїну.
10. Які переваги дієтичної добавки МЕНОРАГІН®?
a. М’який фізіологічний кровоспинний ефект.
b. Курс прийому до 5 днів.
c. Не викликає тромбозів.
d. Зручна лікарська
e.
10.10
25.10
МЕРЕЖА
9-1-1
працює там,
де людям
найбільше
потрібні ліки
4 серпня 2023 року уряд ухвалив постанову, яка дозволяє
А вже 18 січня 2024 року вийшла в рейс перша в Україні
9-1-1 на колесах. Цьому передувала робота юристів Аптечної мережі 9-1-1, які ретельно готували дозвільні документи згідно з ліцензійними умовами — до цього таких прецедентів не було! І лише після цього Державна служба України з лікарських засобів та контролю за наркотиками внесла перший мобільний аптечний пункт до
АПТЕКИ У мобільному аптечному пункті люди можуть
попит на цю послугу через те, що там немає працюючих аптек. Маршрути мобільних аптек плануються заздалегідь, але напередодні виїзду представник офісу Аптечної мережі 9-1-1 телефонує місцевим старостам і з’ясовує ситуацію, адже обстріли — не дивина в прифронтових
Як тільки місцеві громади Харківщини дізналися про запуск першої мобільної аптеки, почали надходити запити з проханням приїхати до них. Але за правилами мобільний аптечний пункт може надавати свої послуги лише там, де не зареєстровані будь-які аптеки. На Харківщині під час повномасштабного вторгнення чимало аптек, зокрема приватних, зачинилися, але офіційно вони існують, хай і тільки де-юре.
Потрібно було зв’язуватися з власниками зареєстрованих аптек і з’ясовувати їхню готовність відновити роботу своїх торгових точок. Якщо ФОП не планував відкриватися знову, його просили анулювати свою ліцензію. Дехто погоджувався, наприклад,
Вовчанського, Чугуївського, Богодухівського, Ізюмського районів.
коли ми приїжджаємо! Особливо, коли вони дізнаються, що в нас є «Доступні ліки». Це ж для стареньких, які рахують кожну копійчину, — справжній порятунок. Вони стоять за ними в черзі, навіть під час тривоги та обстрілів. Ще й мене заспокоюють: «Не бійся, доню, то далеко. Я чула звук, точно кажу». Я ніколи не вдягаю бронежилет під час обслуговування, інакше як я дивитимуся їм в очі? Вони ж без броників. Інша справа, коли переїжджаємо з одного села в інше. Ризики великі, це ж Харківщина, прилетіти може будь-куди і будь-коли. У дорозі і я, і водій обов’язково в бронежилетах, а іноді ще й
Марина Ковтун та
Марина Перепечена, а доставляє їх на місце водій Владислав Біляєв. Він, до речі, суворо контролює ситуацію і дотримання безпеки як в дорозі, так і під час зупинок в селищах.
Марина Ковтун харків’янка, закінчила фаховий коледж і зараз навчається в Національному фармацевтичному університеті. Початок повномасштабного вторгнення зустріла в «Аптеці 9-1-1» на Французькому бульварі, де працювала до того моменту, поки не перейшла в мобільну аптеку.
Дуже жаль людей, вони пережили багато горя, тому особливо цінують, коли про них піклуються. Постійно дякують і просять бути обережними. Ми зазвичай приїжджаємо на півтори-дві години, але залишаємося стільки, скільки потрібно, щоб всі могли придбати необхідне».
Марина Перепечена, випускниця Національного фармацевтичного університету, сама запропонувала свої послуги, коли побачила в робочій групі оголошення про те, що шукають фармацевтів у мобільний аптечний пункт.
«Я виїжджала в Березовку, Ватутіне, Просяне. Суттєвих відмінностей у роботі
У Херсонській області працює 12 аптек Аптечної мережі 9-1-1: сім в обласному центрі, дві в селищі Білозірка та по одній в Великій Олександрівці, Високопіллі та Нововоронцовці. Дві з них першими
Аптека на колесах обслуговує жителів Великоолександрівської, Високопільської, Кочубеївської, Борозенської, Калинівської, Милівської та Нововоронцовської громад Херсонщини. Щодня мужня команда, що складається з фармацевта Вікторії Говорущак та водія Володимира Подрепного, відвідує 3–4 селища, де сільчани заздалегідь займають чергу. Про приїзд Аптеки 9-1-1 вони дізнаються від сімейного лікаря чи представника
c.73
Використання лаку для нігтів
200 у хворих
ураженнями нігтів
c.78
Магнокс® Леді — комфортний перехiд в менопаузу
c.85
Катарія — швидка допомога при циститі
інфекція у хворих на червоний плискатий лишай, псоріаз, екзему сенсибілізує організм, що призводить
ураження нігтьової пластини грибами різних родин порушується її цілісність, змінюється колір і прозорість, зменшується щільність прилягання до нігтьового ложа, товщина тощо. Оніхомікоз є грибковою інфекційною оніходистрофією. До факторів ризику оніхомікозів відносять похилий та старечий вік, порушення периферичного крово-
зараження,
себе фактор
схильності до розвитку цього захворювання [4].
Швидке розповсюдження оніхомікозів також відбувається за рахунок постійної мікротравматизації та порушення цілісності нігтьового апарату. Це відбувається, як правило,
білків та атеросклеротичних уражень, котрі закладають основу формування мікро- та макроангіопатій, порушень роботи серця, розвитку варикозного симптомокомплексу та формування трофічних виразок. Встановлено, що частота оніхомікозів у ВІЛ-інфікованих значно вище загальнопопуляційної та досягає 40 % [5].
Ураження нігтьових пластин відбувається майже в половині випадків
(до 80 % випадків) [6].
роду Candida spp, що більше вражають нігті на руках, визначаються рідше — (приблизно у 10 % випадків) та уражають здебільшого пацієнтів з хронічним кандидозом шкіри і слизових оболонок. Пліс-
няві гриби, такі як Aspergillus spp., Scopulariopsis brevicaulis, Fusarium spp., Acremonium spp., Scytalidium spp. та деякі інші, є причиною близько 10–15 %
випадків оніхомікозів [7].
1. Вид збудника. Мікологічна діагностика дерматомікозів заснована на мікроскопічному, якщо можливо, флуоресцентно-оптичному виявленні грибкових гіф та спор на шкірних лусочках та обрізках нігтів. Культуральне виявлення дерматофітів, дріжджів та плісняви дозволяє визначити вид грибка-збудника, але часто виявляється безуспішним, особливо у пацієнтів, які вже лікувалися протигрибковими засобами. Враховуючи високу чутливість та специфічність молекулярних методів виявлення грибків порівняно з культурою, полімеразну ланцюгову реакцію (ПЛР) можна вважати золотим стандартом діагностики дерматофітій. Комплексна діагностика, що складається з трьох основних факторів — підготовки, культури, ПЛР, нині дає найкращі результати.
2. Підтип оніхомікозу, залучення матриці, кількість уражених нігтів, місце ураження (нігті на руках чи ногах), товщина нігтьової пластини та співіснування
Метою терапії є знищення збудника, яке підтверджене негативною
(Onychomycosis Severity
та
мікроскопічним дослідженням, і регресія симптомів, а також відновлення нормального стану нігтьових пластин.
Одним з найбільш ефективних методів лікування оніхомікозу є комбіноване застосування антимікотиків системної дії (тербінафіну, ітраконазолу, флуконазолу) й топічних протигрибкових лікарських засобів, таких як циклопірокс, аморолфін, ефінаконазол, що підтверджено численними дослідженнями [9, 12]. Системні та топічні протигрибкові препарати
клінічних ситуацій лікар-дерматолог може рекомендувати пацієнтам місцеве лікування оніхомікозів. Рішення про місцеву терапію може бути прийняте при легкому протіканні захворювання; наявності у пацієнта супутніх захворювань, при яких протипоказане використання системних протигрибкових препаратів; особливостей та певних суб’єктивних обставин пацієнта (рис. 1).
Найбільш поширеною формою ураження нігтя
викликаний Trichophyton
засобів. Антимікотичний профіль циклоспоріксу
(T. rubrum, Epidermophyton occosum, Microsporum canis, Trichophyton mentagrophytes), так
Candida spp. (C. glabrata
(Escherichia coli, Pseudomonas aeruginosa, Salmonella typhimurium, Klebsiella aerogenes, Enterobacter cloacae, Gardnerella vaginalis),
[15].
теріальну дії. Виражена протигрибкова дія циклопіроксу обумовлена його активністю по відношенню до основних збудників, що виявляються при грибкових ураженнях нігтів: дерматофітів (Trichophyton, Microsporum canis, Epidermophyton), дріжджів роду Candida, пліснявих грибів. Механізм протигрибкової дії циклопіроксу пов’язаний з проникненням діючої речовини в нігтьову пластину
скорочується.
Висновки
Лак для нігтів «ЦИКЛО-200» — топічний антимікотик, що містить циклопірокс, є оптимальним вирішенням проблеми оніхомікозу як у комплексному застосуванні з системними протигрибковими препаратами, так і при самостійному використанні у широкого кола пацієнтів. Література
1. Sigurgeirsson B, Baran R. e prevalence of onychomycosis in the global population: a literature study. J Eur Acad Dermatol Venereol. 2014;28(11):1480–1491. doi: 10.1111/jdv.12323
2. Gupta AK, Stec N, Summerbell RC, et al. Onychomycosis: a review. J Eur Acad Dermatol Venereol. 2020;34(9):1972–1990. doi: 10.1111/jdv.16394
3. Gupta A., Jain H., Lynde C. et al. Prevalence and epidemiology of onychomycosis in patients visiting physicians’ o ces: a multicenter Canadian survey of 15,000 patients // J. Am. Acad. Dermatol. — 2000; 43: 244–8.
4. Faergemann J., Correia O., Nowicki R. et al. Genetic predisposition — understanding underlying mechanisms of onychomycosis // J. Eur. Acad. Dermatol. Venerol. — 2005; 19: 17–9
5. Vasudevan Biju. Cutaneous manifestations of HIV — a detailed study of morphological variants, markers of advanced disease, and the changing spectrum // Med. J. Armed Forces India. — 2012; 68: 20–27.
6. Havlickova A., Czaika V., Friedrich M. Epidemiological trends in skin mycoses worldwide // Mycoses. — 2008; 51 (4): 2–15.
7.
9. Gupta A.K., Venkataraman M., Renaud H.J., Summerbell R., Shear NH, Piguet V. A paradigm shi in the treatment and management of onychomycosis.Skin Appendage Disord. 2021;7(5):351–358. doi: 10.1159/000516112
10. Gupta A.K., Cernea M., Foley K.A. Improving Cure Rates in Onychomycosis. J Cutan Med Surg. 2016;0(6):517–531. doi: 10.1177/1203475416653734
11. Bristow I.R., Baran R. Topical and oral combination therapy for toenail onychomycosis: an updated review. J Am Podiatr Med Assoc.2006;96(2):116–119. doi: 10.7547/0960116
12. Gupta A.K., Versteeg S.G.., Shear N.H. Onychomycosis in the 21st century: an update on diagnosis, epidemiology, and treatment. J Cutan Med Surg. 2017;21(6):525–539. doi: 10.1177/1203475417716362
13. Kreijkamp-Kaspers S., Hawke K., Guo L. et al. Oral anti fungal medication for toenail onychomycosis // Cochrane DatabaseSyst. Rev.— 2017.— N 7.— Cd010031.
14. CLogP (Daylight Chemical Information Systems). http://www.daylight.com/ daycgi/clogp
15. Gupta A.K., Plott T. Ciclopirox: a broad-spectrum antifungal with antibacterial and anti-in ammatory properties. Int J Dermatol 2004; 43 (Suppl. 1): 3–8.
Aêîìôîðòíèé
Олена Шуванова, кандидат фармацевтичних
наук, Національний фармацевтичний університет
«Дивовижно! І коли вона все це встигає?» Саме так ми говоримо про молодих енергійних жінок, які
працюють, виховують дітей, займаються хатніми справами, активно відпочивають, доглядають за собою, та ще й і вирішують безліч дрібних побутових проблем. Як же їм це вдається? Щоб зрозуміти, розглянемо результати експерименту, в ході якого жінкам і чоловікам дали
і обмежили час на його виконання. На відміну від чоловіків, які
Фази клімаксу та його симптоми
Клімакс (від грец. climacter — щабель сходів) — перехідний
період від репродуктивної фази до
постменопаузи.
Вирізняють 3 фази клімаксу:
Пременопауза починається зазвичай
після 45 років і триває від 2 до 6 років. Основна
великої кількості холестерину, що може провокувати захворювання серцево-судинної системи;
вимивання кальцію з організму, яке призводить до крихкості кісток — остеопорозу;
хронічних захворювань тощо. Симптоми менопаузи у
НАСКІЛЬКИ ПОШИРЕНІ
ПРОЯВИ КЛІМАКТЕРИЧНОГО СИНДРОМУ?
Про припливи повідомляють до 85 % жінок. При цьому у 55 % вони починаються до початку порушення менструального циклу і тривають 4–5 років.
Про порушення сну на час настання постменопаузи повідомляють понад 50 % жінок.
Схильні до депресії у період менопаузи приблизно 20 % жінок.
Про погіршення пам’яті та концентрації уваги під час менопаузи повідомляють 62–82 % жінок.
У 50 % жінок із настанням менопаузи розвивається артеріальна гіпертензія та ішемічна
старінням.
який
зниження настановної точки терморегуляції. Показано, що до припливу та під час нього рівень метаболітів норадреналіну в плазмі крові підвищується, в результаті настановна точка терморегуляції знижується, що призводить до розширення судин та відчуття припливу [6]. Для полегшення симптомів клімаксу варто дотримуватись таких принципів: Здорове харчування. Раціон повинен містити овочі та фрукти, морепродукти, нежирне м’ясо, яйця, молочні продукти.
Регулярна фізична активність.
У випадках складного перебігу — замісна гормонотерапія.
застосовуються препарати, що містять естроген та прогестерон. Лікарі рекомендують використовувати індивідуально підібрані гормональні препарати в мінімальних дозах, тому що у деяких жінок при тривалому використанні ці препарати збільшують ризик розвитку раку молочної залози, інфаркту міокарда та тромбозу; викликають такі побічні ефекти, як болючість
NOTA BENE!
Клімакс — не захворювання. Це природний процес в житті кожної жінки. Варто
певних симптомів, які турбують
найбільше. Альтернативні (негормональні) методи лікування проявів клімаксу полягають у призначенні фітопрепаратів, харчових добавок, транквілізаторів, гомеопатичних лікарських засобів як окремо, так і в різних поєднаннях.
NOTA BENE!
, що традиційно застосовуються як натуральні заспокійливі засоби, допомагають покращити емоційний стан і вирівняти настрій. Полегшенню засинання, підвищенню тривалості та якості сну сприяє мелатонін, а вітаміни
системи [9].
Зменшує частоту та вираженість припливів завдяки комп-
Сприяє полегшенню засинання, підвищенню тривалості та якості сну,
препарати магнію змінюють ефект хронічного стресу, виникла в 1981 р. Пізніше
було доведено, що гострий стрес пов’язаний зі збільшенням виведення магнію із сечею [5]. Найцікавіше те, що дефіцит магнію не викликає певної патології, але знижує толерантність до вторинного стресу [8].
Мелатонін є природною речовиною, що відповідає за нормальний сон, але з віком рівень ендогенного мелатоніну знижується. Особливо яскраво ця динаміка прослідковується у жінок в
період менопаузи. Дослідження концентрації мелатоніну в слині жінок довели, що у менопаузі порушення сну пов’язані зі зміненою секрецією мелатоніну протягом доби [2]. Доведено, що мелатонін справляє протитривожну й антидепресивну дію, знижує рівень загального холестерину, бере участь у регуляції артеріального тиску у спокої та при психоемоційному навантаженні. За рахунок антиоксидантних властивостей мелатонін є своєрідним стресопротектором для серцево-судинної системи, що актуально для жінок у період менопаузи, коли значно підвищується ризик серцево-судинних розладів [10].
Екстракт квітки пасифлори інкарнатної застосовують як заспокійливий засіб у хворих з неврастенічними скаргами та вегетативними порушеннями на тлі різних захворювань нервової системи, коли відзначаються скарги на підвищену дратівливість, нервозність, ослаблення гальмівних реакцій, порушення сну, серцебиття. Позитивні результати відзначені при лікуванні препаратами пасифлори жінок у клімактеричному періоді, при підвищеній нервозності,
формах порушень сну.
Цинк необхідний для синтезу та балансу гормонів, регулює секрецію кальцитоніну з щитовидної залози та впливає на обмін кісток. Згідно з результатами досліджень, мінеральні добавки, особливо з кальцієм, магнієм і цинком можуть мати сприятливий вплив на щільність кісткової тканини у жінок у постменопаузі. Також було доведено, що підвищення рівня цинку впливає на стабілізацію емоційного стану [4].
Zn
B6
Піридоксину гідрохлорид (Вітамін В) — відіграє важливу роль в обміні речовин, необхідний для нормального функціонування центральної та периферичної нервової системи, бере участь у синтезі нейромедіаторів. Він необхідний організму як кофактор для вироблення серотоніну, що регулює настрій. Вітамін В6 сприяє підвищенню стресостійкості та концентрації, запобігає різноманітним нервовим розладам.
Тіаміну хлорид (Вітамін В) в організмі
перетворюється на кокарбоксилазу, яка є коферментом багатьох ферментних реакцій. Вітамін В1 відіграє важливу роль в
B1
обміні речовин та нервово-рефлекторній регуляції, впливає на проведення нервового збудження в синапсах. Його називають «вітаміном бадьорості», оскільки він сприяє перетворенню поживних речовин на енергію. Тіамін корисний для стабілізації психоемоційного стану, покращує розумові здібності, позитивно впливає на серце та судини.
Ціанокобаламін (Вітамін В) проявляє метаболічну, гемопоетичну дію, знижує рівень холестерину в крові. Він позитивно впливає на функцію печінки та нервової системи, має легкий седативний ефект, підвищує стійкість до стресу та депресії.
Дієтичну добавку МАГНОКС® ЛЕДІ рекомендовано споживати по 1–2 капсу-
склянкою води. На жінок традиційно покладається відповідальність
про інших членів родини, тому їхній емоційний стан і працездатність
Література
1. ACOG practice bulletin No. 141: management of menopausal symptoms. Obstet Gynecol. 2014. Vol. 123. P. 202–216
2. Bellipanni G., Bianchi P., Pierpaoli W. et al. E ects of melatonin in perimenopausal and menopausal women: a randomized and placebo controlled study. Exp. Gerontol. 2001. Vol. 36. № 2. P. 297–310.
3. Charles L. Loprinzi et al. Nonestrogenic Management of Hot Flashes. JCO. 2011. Vol. 29. P.3842–3846. DOI:10.1200/ JCO.2011.37.5865
4. Mahdavi-Roshan M, Ebrahimi M, Ebrahimi A. Copper, magnesium, zinc and calcium status in osteopenic and osteoporotic post-menopausal women. Clin Cases Miner Bone Metab. 2015 Jan-Apr;12(1). P.18–21. doi: 10.11138/ ccmbm/2015.12.1.018. PMID: 26136790; PMCID: PMC4469220.
5. Murck H. Magnesium and a ective disorders. Nutr Neurosci. 2002. №5. P. 375–389.
6. Politi M.C., Schleinitz M.D., Col N.F. Revisiting the duration of vasomotor symptoms of menopause: a meta-analysis. J Gen Int Med. 2008. Vol. 23. P. 1507–1513.
7. Smith TJ: Magnesium supplements for menopausal hot ashes. J Clin Oncol. 2009. Vol. 27. P. 1151–1152.
8. Tejero-Taldo MI, Kramer JH, Mak Iu T, Komarov AM, Weglicki WB. e nerve-heart connection in the pro-oxidant response to Mg-de ciency. Heart Failure Rev. 2006. №11. P. 35–44.
9.
capsules. 10.
Ганна Кирпач, лікар A ЧОМУ ВИНИКАЄ
діяльності вітаміни
засвоювати їжу. Проте деякі наші органи повинні залишатися повністю стерильними, тобто вільними від бактерій. Це стосується і сечової системи. При потраплянні бактерій у сечовий міхур він запалюється, що й викликає симптоми циститу [2]. Кишкова паличка є найбільш поширеним збудником інфекцій сечовивідних шляхів (ІСШ) у жінок, зокрема й циститу, та відповідає за 75–95 % захворювань. Інші збудники включають види сімейства Enterobacteriaceae, такі як Proteus mirabilis та Klebsiella pneumoniae та інші бактерії, наприклад Staphylococcus saprophyticus [4–8].
катетеризація сечового міхура;
статевий акт, особливо при зміні статевого партнера;
використання
нують сперму (сперміцидів) та діафрагм;
проведення гінекологічного огляду та гінекологічних процедур;
цукровий діабет.
Причиною циститу в чоловіків найчастіше є бактеріальна
відтоку
натися у відсутності цих серйозних захворювань [17].
Як запідозрити цистит? Найбільш частими скарга-
при циститі є [1, 18]:
при сечовипусканні;
часте сечовипускання;
позиви до сечовипускання вночі. ! Температура тіла при циститі зазвичай не підвищується.
вивідних шляхів); ускладнений цистит (до ускладнюючих чинників відносять супутній цукровий діабет,
достатньо характерних скарг і відсутності виділень із піхви, які
вказувати на запалення статевої, а не сечової системи. Інколи при виникненні сумнівів призначають додаткові аналізи [1, 2, 19]. Загальний аналіз
Лікування циститу включає:
знешкодження збудника захворювання (бактерій, рідше вірусів та найпростіших);
зменшення симптомів захворювання.
Для лікування причин циститу використовують
антибактеріальні засоби, в першу чергу — фосфоміцину трометамол або нітрофурантоїн [20–23]. Якщо ці препарати не можна призначати через непереносимість або неефективність, призначають триметоприм у поєднанні з сульфануламідом [25, 26]. Оскільки цистит у чоловіків частіше виникає на тлі простатиту, потрібно призначати антибіотики, які пронікають у тканину передміхурової залози.
Для цього використовують триметоприм у поєднанні з сульфануламідом або фторхінолони, наприклад левофлоксацин [17].
Раніше для лікування циститу успішно використовували амінопеніциліни, проте в останні роки E. coli стала нечутливою до цих антибіотиків [27, 28].
На жаль, навіть правильно підібраний антибіотик відразу не зменшує вираженість та тяжкість таких симптомів циститу, як біль, позиви та різі при
із симптомами циститу, у яких не було чітких клінічних ознак бактеріальної інфекції. Цитрат натрію призначався в по 4 г 3 р/д протягом 48 годин. В результаті важкість
із початковою бактеріурією зменшувалися у 80% випадків. Було зроблено висновок, що 48-годинний курс цитрату натрію може забезпечити хороше симптоматичне полегшення для більшості жінок із циститом [30]. Цитрат натрію,
1. European Association of Urology. EAU Guidelines on Urological Infections, 2019.
2. John L. Brusch. Urinary Tract Infection (UTI) and Cystitis (Bladder Infection) in Females.
3. Горелов А.В., Каннер Е.В.,
Lactobacillus rhamnosus GG:
с позиций доказательной медицины. Медицинский Совет. 2018;(17):66-73.
4. Byron JK. Urinary Tract Infection. Vet Clin North Am Small Anim Pract. 2019 Mar;49(2):211-221.
5. Karamali M, Shafabakhsh R, Ghanbari Z, E ekhar T, Asemi Z. Molecular pathogenesis of interstitial cystitis/bladder pain syndrome based on gene expression. J Cell Physiol. 2019 Aug;234(8):12301-12308.
6. Rank EL, Lodise T, Avery L, Bankert E, Dobson E, Dumyati G, Hassett S, Keller M, Pearsall M, Lubowski T, Carreno JJ. Antimicrobial Susceptibility Trends Observed in Urinary Pathogens Obtained From New York State. Open Forum Infect Dis. 2018 Nov;5(11):ofy297.
7. Talan DA, Takhar SS, Krishnadasan A, Abrahamian FM, Mower WR, Moran GJ., EMERGEncy ID Net Study Group. Fluoroquinolone-Resistant and Extended-Spectrum β-Lactamase-Producing Escherichia coli Infections in Patients with Pyelonephritis, United States(1). Emerg Infect Dis. 2016 Sep;22(9)
8. Colpan A, Johnston B, Porter S, Clabots C, Anway R, ao L, Kuskowski MA, Tchesnokova V, Sokurenko EV, Johnson JR., VICTORY (Veterans In uence of Clonal Types on Resistance: Year 2011) Investigators. Escherichia coli sequence type 131 (ST131) subclone H30 as an emergent multidrug-resistant pathogen among US veterans. Clin Infect Dis. 2013 Nov;57(9):1256-65.
9. Lynda A. Frassetto. Nonbacterial and Noninfectious Cystitis.
10. Perez CA, Lee HK, Georgiou A, Lockett MA. Technical factors a ecting morbidity in de nitive irradiation for localized carcinoma of the prostate. Int J Radiat Oncol Biol Phys. 1994 Mar 1. 28(4):811-9.
11. Martin-Suarez I, D’Cruz D, Mansoor M, Fernandes AP, Khamashta MA, Hughes GR. Immunosuppressive treatment in severe connective tissue diseases: e ects of low dose intravenous cyclophosphamide. Ann Rheum Dis. 1997 Aug. 56(8):481-7
12. Teegavarapu PS, Sahai A, Chandra A, Dasgupta P, Khan MS. Eosinophilic cystitis and its management. Int J Clin Pract. 2005 Mar. 59(3):356-60.
13. [Guideline] Hooton TM, Bradley SF, Cardenas DD, et al. Diagnosis, prevention, and treatment of catheter-associated urinary tract infection in adults: 2009 International Clinical Practice Guidelines from the Infectious Diseases Society of America. Clin Infect Dis. 2010 Mar 1. 50(5):625-63.
14. Tiemstra JD, Chico PD, Pela E. Genitourinary infections a er a routine pelvic exam. J Am Board Fam Med. 2011 May-Jun. 24(3):296-303.
15. Foxman, B. Epidemiology of urinary tract infections: incidence, morbidity, and economic costs. Dis Mon, 2003. 49: 53.
16. Naber, K.G., et al. Surveillance study in Europe and Brazil on clinical aspects and Antimicrobial Resistance Epidemiology in Females with Cystitis (ARESC): implications for empiric therapy. Eur Urol, 2008. 54: 1164.
17. Wagenlehner, F.M., et al. Antimicrobials in urogenital infections. Int J Antimicrob Agents, 2011. 38 Suppl: 3.
18. Li R, Leslie SW. Cystitis. [Updated 2021 Jul 9]. In: StatPearls . Treasure Island (FL): StatPearls Publishing; 2021 Jan
19. Richard Colgan, Mozella Williams. Diagnosis and Treatment of Acute Uncomplicated Cystitis. Am Fam Physician. 2011 Oct 1;84(7):771-776.
20. Gupta, K., et al. Short-course nitrofurantoin for the treatment of acute uncomplicated cystitis in women. Arch Intern Med, 2007. 167: 2207.
21. Lecomte, F., et al. Single-dose treatment of cystitis with fosfomycin trometamol (Monuril): analysis of 15 comparative trials on 2,048 patients. Giorn It Ost Gin, 1997. 19: 399.
22. Nicolle, L.E. Pivmecillinam in the treatment of urinary tract infections. J Antimicrob Chemother, 2000. 46 Suppl 1: 35.
23. Huttner, A., et al. Nitrofurantoin revisited: a systematic review and metaanalysis of controlled trials. J Antimicrob Chemother, 2015. 70: 2456.
24. Gupta, K., et al. Outcomes associated with trimethoprim/ sulphamethoxazole (TMP/SMX) therapy in
25. TMP/SMX resistant community-acquired UTI. Int J Antimicrob Agents, 2002. 19: 554.
26. Warren, J.W., et al. Guidelines for antimicrobial treatment of uncomplicated acute bacterial cystitis and acute pyelonephritis in women. Infectious Diseases Society of America (IDSA). Clin Infect Dis, 1999. 29: 745.
27. Hooton, T.M., et al. Cefpodoxime vs cipro oxacin for short-course treatment of acute uncomplicated cystitis: a randomized trial. JAMA, 2012. 307: 583.
28. Hooton, T.M., et al. Amoxicillin-clavulanate vs cipro oxacin for the treatment of uncomplicated cystitis in women: a randomized trial. Jama, 2005. 293: 949.
29. Ueda T, Yoshida T, Tanoue H, Ito M, Tamaki M, Ito Y, Yoshimura N. Urine alkalization improves the problems of pain and sleep in hypersensitive bladder syndrome. Int J Urol. 2014 May;21(5):512-7. doi: 10.1111/iju.12324. Epub 2013 Nov 13. PMID: 24224617.
30. Spooner JB. Alkalinisation in the management of cystitis. J Int Med Res. 1984;12(1):30-4. doi: 10.1177/030006058401200105. PMID: 6692966.
31. Gargan RA, Hamilton-Miller JM, Brum tt W. E ect of alkalinisation and increased uid intake on bacterial phagocytosis and killing in urine. Eur J Clin Microbiol Infect Dis. 1993 Jul;12(7):534-9. doi: 10.1007/BF01970959. PMID: 8404914.